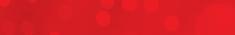

DE SCHAKE L

Zorgtrajectbegeleider ondersteunt bij dementie

33e Handreiking tussen De Keien en De Bremspoersen

Carnaval bij De Keien en in De Pracht: een overzicht

Verlies voor DVS en Waalre, winst voor Willem en Fenna



Zorgtrajectbegeleider ondersteunt bij dementie

33e Handreiking tussen De Keien en De Bremspoersen

Carnaval bij De Keien en in De Pracht: een overzicht

Verlies voor DVS en Waalre, winst voor Willem en Fenna

Vrijdag barst het feest der feesten al op veel plaatsen los en daarna is het tot en met dinsdag 17 februari volop feest in Waalre en omgeving. De weersverwachting ziet er niet zo best uit dus laten we duimen dat het meevalt met de regen en voorspelde kou.
WAALRE - Wonen Welzijn Zorg Waalre (WWZ Waalre) hield woensdag 4 februari een avond voor inwoners over samen ouder worden in Waalre. Tachtig belangstellenden kwamen samen in de Agnus Deikerk. Het publiek kreeg niet alleen informatie, maar werd ook zelf aan het werk gezet.
Door Wilma Stofmeel
De presentatie was in handen van Huub Cornelissen van Samen Leren Ouder Worden (SLOW). Verder werkten mee: Jim Steenbakker van Programma Precies de Juiste Zorg en Tony Liebregts van WWZ Waalre en Marjolein Blom. Na zijn welkomstwoord legde Huub Cornelissen uit wat er die avond op de agenda stond. Iedereen had een naamsticker ontvangen met een groepsnum-

mer. Er zouden die avond twaalf groepen met elkaar in gesprek gaan. Vervolgens gaf Tony Liebregts nog een korte terugblik op de voorgaande samenkomsten waarna iedereen werd verzocht de eigen groep te zoeken in de verschillende locaties in de kerk.
Wat gaat goed, wat kan beter Begin januari vond een bijeenkomst plaats waar tweeënvijftig organisaties aan deelnamen. Zij bespraken ‘wat gaat goed in Waalre en wat kan beter’. Samen hebben ze een ‘droom’ geschetst van wat ze eind 2027 bereikt hebben. Marjolein Blom: “Vanavond is het de beurt aan de inwoners. Zij krijgen de opdracht in kleine groepen met elkaar in gesprek te gaan over: Waar ben je bang voor, waar heb je behoefte aan en wat hoop je dat er eind 2027 gerealiseerd kan worden? Daarna komt iedereen weer in de zaal bij elkaar om het resultaat van dit overleg te bespreken. Vervolgens gaan de mensen nog een keer in groepjes rond de tafel zitten om te overleggen wat zij in de krant hopen te kunnen zetten.”
Als je kijkt waar de avond over gaat, zou je het idee kunnen krij-

De mooiste lezersfoto’s van deze week


gen dat het ‘open deuren zijn’. Tony Liebregts: “Het zijn open deuren, maar het is goed dat die uitgesproken worden want de organisaties in januari roepen hetzelfde als wij. We hebben het over hetzelfde. Als we samen door de open deur gaan, dan kunnen we wat bereiken. Als we roepen en er gebeurt niets, dan zullen we niet veel bereiken. Dat is wat we doen, dingen bij elkaar brengen, bouw een netwerk.”
Lees verder op pagina 3













Vanaf 1 maart 2026 geopend
D e Lees akker 27, Waalre www.kinderdagverblijfcasita.nl








ZATERDAG 14 FEBRUARI VALENTIJNSDAG

Valkenswaard | Handwerkstraat 10b | 040-2014736 www.martinezchocolade.nl
Aalsmeer Alphen Amstelveen Amsterdam Emmeloord Hoofddorp Hoogvliet Valkenswaard
VACATUREBANK Valkenswaards weekblad februari 2026
Is jouw goede voornemen om dit jaar meer te doen voor een ander? Vanuit de Vrijwilligerscentrale Valkenswaard kunnen we samen kijken naar de verschillende mogelijkheden voor vrijwilligerswerk. Ga naar https://www.vrijwilligerscentralevalkenswaard.nl/ of maak een afspraak.
Vrijwilliger thuisadministratie gezocht
Heb jij affiniteit met administratie en wil je iets betekenen voor een ander?
Bij Cordaad Welzijn help je mensen thuis met hun administratie en financiën. Zo breng je samen meer overzicht en rust. Je bepaalt zelf je inzet en staat er nooit alleen voor. Interesse? Kijk op bovenstaande website
Dringend Secretaris en Penningmeester gezocht Senioren Valkenswaard
De taken van de secretaris zijn: - het ontvangen van post, voornamelijk per e-mail, dit doorsturen naar de overige bestuursleden en hiervan een overzicht bijhouden; -een agenda, verslag en actielijst maken van de maandelijkse bestuursvergaderingen en de jaarvergadering; -het voeren van de externe correspondentie. -Samen met de voorzitter toezien dat alle afgesproken acties worden uitgevoerd. De taken van de penningmeester zijn : beheert de geldmiddelen, voert een overzichtelijke boekhouding van de inkomsten en uitgaven, brengt op de jaarvergadering financieel verslag uit met een rapport van de controlecommissie. geeft het afdelingsbestuur tijdens de bestuursvergaderingen inlichtingen over de stand van de financiën, regelt de inning van de contributie en eventuele subsidieaanvragen. Heeft u interesse dan kunt u contact opnemen via e-mail: seniorenvwaard.secretariaat@gmail.com
Vrijwilligers voor NLDoet op za. 14 maart 2026 bij WeDommelen
Vanuit de gemeente doen we mee met het bloemzadenproject. Het leek ons leuk om het uitdelen van de zakjes met bloemzaden plaats te laten vinden in onze biologische buurtmoestuin die op dat moment 1 jaar bestaat en al vele bewoners gelukkig heeft kunnen maken met een rijkelijke groei van groenten, fruit en bloemen. Tegelijkertijd willen we ook aandacht besteden aan onze Mozaïekwandelroute. Door werkzaamheden in de wijk gaan er regelmatig gemozaïekte stoeptegels kapot en moeten deze hersteld worden. Verder willen we onderhoud doen aan onze beweegroute.
Penningmeester KansPlus Valkenswaard
Je speelt een rol in het waarborgen van een gezonde financiële positie, zodat onze vereniging haar doelstellingen voor mensen met een verstandelijke beperking en die van de diverse vrijetijdclubs voor onze doelgroep kan blijven vervullen. Je maakt ook deel uit van het bestuur. Per jaar stel je de begroting op en regel je de aanvraag van de subsidie bij de gemeente Valkenswaard en Stichting de Carrousel. Benodigde kennis van werken met word en Exel. Verder is kennis van financiële administratie een pre om deze functie te kunnen vervullen. Heb je interesse om onze nieuwe penningmeester te worden? Of ken je iemand die dat wel zou willen doen? Neem dan contact op met onze secretaris Jan Tillemans, jmhatillemans@onsbrabantnet.nl, of 0653772015
Secretaris Parkinson2Beat Parkinson2beat maakt gebruik van bekende programma’s als Word, Outlook, Excel en Teams. Indien nodig zorgen wij dat u hier de beschikking over krijgt. Tijdbeslag is tussen de 2 en de 4 uur per week. U kunt dit gewoon vanaf uw eigen huis doen.
Voor meer informatie neem contact op met Cordaad Welzijn Vrijwilligerscentrale. De Hofnar 12, 5554 DA Valkenswaard. 06-13276370/06-23252348 E-mail: E-mail: lvrijwilligerscentraleva@cordaadwelzijn.nl. Website: https://www.vrijwilligerscentralevalkenswaard.nl / Spreekuur: op afspraak.
Gezocht hulp in de huishouding in Aalst wij wonen tussen Valkenswaard en Aalst voor om de 2 weken 4 uurtjes of in overleg. 17.50 p/u. Graag reageren op info@lisseven.nl of 0653122661 Groet Hanneke.

Sloopauto’s gevraagd, hoge prijs, direct opgehaald. P. de Beer. 040-2435700






WAALRE - In de gemeente Waalre zijn drie zorgtrajectbegeleiders werkzaam die thuiswonende mensen met beginnende dementie, hun partners, familieleden en mantelzorgers ondersteunen. Sophia Aerssens, Karlijn van Gerven en Diana Geraerts werken voor Ketennetwerk Dementie Eindhoven en omgeving.
Vergeetachtigheid en dementie zorgen bijna altijd voor vragen en onzekerheid. De cliënt en mantelzorger zien soms door de bomen het bos niet meer en weten niet waar ze welke hulp kunnen krijgen of aanvragen. De zorgtrajectbegeleider geeft een onafhankelijk advies waarbij de thuissituatie centraal staat.
De zorgtrajectbegeleider:
- biedt praktische ondersteuning bij het vele regelwerk zoals het invullen van bepaalde formulieren; - coördineert de zorg rondom de cliënt en de mantelzorger; - is een vast aanspreekpunt tijdens het hele ziekteverloop rondom dementie; - biedt een luisterend oor en neemt de tijd voor emotionele steun, omdat het vaak een verwarrende en moeilijke tijd is voor de cliënt en de familie.
Informatie en advies
De zorgtrajectbegeleider is deskundig en kan informatie en voorlichting geven over het ver-
Weekblad de Schakel
Uitgever: DAS Mediacentrum
Bezoekadres
Laan ten Roode 71e | 5711 GB Someren
Ma. t/m vr.: 09.00-17.00 uur
T 0493-473578
www.weekbladdeschakel.nl
Correspondentieadres
Laan ten Roode 71e | 5711 GB Someren
Media-adviseur
Marianne van Gelder
T 0493-473578 | M 06-82097740
E deschakelwaalre@dasmediacentrum.nl
Advertenties voor plaatsing op de eerstvolgende woensdag aanleveren vóór maandag 16.00 uur.
Redactie
Pien Buwalda (hoofdredacteur)
M 06-57017064
E deschakel@dasmediacentrum.nl
Berichten voor plaatsing op de eerstvolgende woensdag aanleveren vóór maandag 12.00 uur.
Weekblad de Schakel
Oplage: 8.700 exemplaren Verschijnt op woensdag in Waalre en Aalst.
Bezorgklachten: Via onze website www.weekbladdeschakel.nl
Wij behouden ons ten aanzien van de inhoud van onze artikelen zowel het auteursrecht voor conform art. 15 lid 1 sub 4 van de Auteurswet als het Databankrecht.
Deze krant is aangesloten bij:

loop van de ziekte en nodige zorg. Dit geldt voor het hele traject van diagnose tot aan opname of overlijden.
De hulpverlening vindt bij voorkeur zoveel mogelijk plaats bij de cliënt thuis. Ook in de beginfase is begeleiding vaak welkom. Zo kan het heel moeilijk zijn om iemand met beginnende dementie ervan te overtuigen dat hij of zij zich moet laten onderzoeken en
dat hulp nodig is. Zorgtrajectbegeleiders kunnen hierin een rol spelen.
Wacht niet te lang
Mensen die vragen helpen zichzelf door snel met hun vragen naar de huisarts te gaan. Hij of zij kan dan op tijd zorg inzetten. Daarbij komt dat vergeetachtigheid ook een andere oorzaak kan hebben dan dementie.
Het was duidelijk dat veel mensen dezelfde angsten delen: angst voor slechte gezondheid, afhankelijk worden of eenzaam, hun partner verliezen of geestelijke beperkingen krijgen. Er is behoefte aan: voorzieningen in de buurt, passende woonruimte, sociaal contact, goed openbaar vervoer, hulp in huis en een gemengde woonvorm van jong en oud.
De deelnemers hopen op: vitaal en actief blijven, goede medische zorg krijgen, zelf auto blijven rijden en met elke generatie te kunnen leven. Een groep constateerde dat de drie thema’s samen een driehoek vormen: angst en hoop worden opgelost als de behoeftes worden gerealiseerd.
De tweede opdracht was: Welke droom zou je eind 2027 verwezenlijkt willen zien, in welke krant zou je het zetten en over welke onderwerpen zul je schrijven? Het resultaat was dat veel krantenartikelen zouden gaan over wonen in welke vorm dan ook. Daarnaast over gerealiseerde ontmoetingspunten en dat er meer zorgondersteuning vanuit de gemeente is. Verder dat jong en oud meer samenwerken. De Schakel werd het meest genoemd om daar het goede nieuws in te zetten. Woensdag 17 maart brengt WWZ Waalre de organisaties en inwoners bij elkaar om er samen de schouders onder te zetten. En er komen informatiebijeenkomsten.

Dick de Geus: ‘De sneeuwklokjes
Aanvraag zorgtrajectbegeleiding
De zorgtrajectbegeleider neemt vervolgens contact op met de client en met de familie en komt op huisbezoek. Op die manier ontstaat een beeld van de situatie en kan snel bekeken worden of er zorg nodig is en in welke vorm. Daarna blijft de zorgtrajectbegeleider de cliënt regelmatig bezoeken en houdt het verloop van de dementie in de gaten. Zo kan zo nodig op tijd andere zorg worden
ingeschakeld. Er is regelmatig overleg met de huisarts. Voor meer informatie kunt u contact opnemen met de huisarts of kijken op www.netwerk-dementie.nl
Dementietafel
Iedere eerste donderdag van de maand van 14.00 tot 16.00 uur is er de Dementietafel in de bibliotheek in het Huis van Waalre. De tafel is een ontmoetingsplek voor iedereen die te maken heeft met dementie of daar meer over wil weten.
Een professional en een lid van de werkgroep Dementie Vriendelijk Waalre zijn aanwezig om een luisterend oor te bieden, vragen te beantwoorden en informatie te delen.
Gezond & Actief Waalre
De gemeente Waalre vindt het welzijn van de inwoners belangrijk. Daarom stimuleert zij een gezonde leefstijl, zowel fysiek als mentaal. Rijksoverheid heeft gemeenten de opdracht gegeven om uitvoering te geven aan verschillende gezondheidsthema’s. Dementie is een van deze thema’s. De gemeentelijke werkgroep dementievriendelijk Waalre neemt het initiatief om de kennis over dementie binnen de gemeenschap te vergroten.
Heeft u vragen? Mail deze naar: gezond@waalre.nl.
Carnavalsviering op zondag en askruisje op woensdag

WAALRE - Carnaval is het feest dat voorafgaat aan de Veertigdagentijd. Op carnavalszondag, 15 februari, wordt tijdens de carnavalsviering gebeden om zegen over het carnavalsfeest.
De carnavalsviering begint om 11.00 uur in de Willibrorduskerk in Waalre. Dit is een viering van Woord en gebed die wordt ondersteund door carnavaleske muziek. Voor de zondagsmis zijn parochianen welkom in de OLV Presentatiekerk in Aalst op zaterdag om 17.00 uur en zondag om 09.30 uur.
Aswoensdag
Op Aswoensdag (18 februari) start de Veertigdagentijd, een tijd van vasten en gebed ter voorbereiding op Pasen. Die dag is het mogelijk om het askruisje te ontvangen.
Dit kruisje wordt gemaakt van verbrande palmtakjes.
Bij het askruisje wordt uitgesproken: ‘Gedenk mens dat gij stof zijt en tot stof zult wederkeren’ (Genesis 3:19) of ‘Bekeert u en gelooft in het evangelie’. Zo worden we uitgenodigd tot boete, bezinning en bekering.
Het askruisje wordt uitgereikt tijdens de missen van 18.30 uur in de Willibrorduskerk in Waalre en 20.00 uur in de OLV Presentatiekerk in Aalst.





Nu één zorgtoestel

Heb je het gevoel dat je door gehoorverlies niet helemaal jezelf meer bent? Hou van je oren, gun ze het juiste hoortoestel en blijf jezelf. Maak nu een afspraak; bel 088 – 52 52 052 of ga naar www.audika.nl
Valkenswaard Richterpad 7
* Wij vergoeden voor één toestel wat je zorgverzekeraar niet vergoedt, m.u.v. eigen risico en kosten oplaadbaar. Zie voorwaarden op onze website.
Van Boxtel hoorwinkels heeft een andere naam








NU Het hele jaar open! 1000m2 carnavals plezier




De Hoef 12b Hoogeloon





















Energiecafé: Ontdek hoe je jouw woning isoleert mét subsidie
Wil je jouw energierekening verlagen én comfortabeler wonen? Dan is isoleren een slimme stap. Met de isolatiesubsidie van de gemeente wordt dit extra aantrekkelijk. Tijdens het Energiecafé op woensdag 25 februari leggen de energiegidsen van Vereniging Duurzaam Waalre de gehele subsidieregeling stap voor stap uit.
Naast de landelijke subsidieregeling (ISDE), kan je van de gemeente Waalre tot wel €1500,- subsidie krijgen voor jouw woning. Je woning moet dan wel aan bepaalde voorwaarden voldoen.
Kom naar Het Energiecafé
Op woensdag 25 februari staan de energiegidsen van Vereniging Duurzaam Waalre tussen 19.00 en 21.30 uur voor je klaar in Het huis van Waalre. Zij beantwoorden al
jouw vragen over isoleren en de landelijke én gemeentelijke subsidies. Om 19.15 uur start ook een korte presentatie over de subsidieregelingen en krijg je alle informatie die je nodig hebt.
Meld je nu aan!
Aanmelden voor Het Energiecafé kan door een mail te sturen naar duurzaam@waalre. nl. Heb je een korte vraag voor de Energiegidsen? Loop gerust binnen.

Vanwege carnaval is de gemeentebalie gesloten en is de gemeente telefonisch niet bereikbaar op maandag 16 februari. Vanaf dinsdag 17 februari zijn wij weer bereikbaar. Voor acute crisissituaties op het gebied van zorg en welzijn waarbij direct hulp nodig is, kun je contact opnemen met het noodnummer van het Centrum voor Maatschappelijke Deelname via 040-2282575. Wij wensen iedereen een fijne carnaval!
De Meedoenbijdrage wordt ook in 2026 automatisch verstrekt!
De bijdrage is ervoor bedoeld om mee te kunnen doen aan activiteiten in het algemeen. Bijvoorbeeld voor een lidmaatschap van een (sport-)vereniging of een bezoek aan een pretpark, een bezoek aan een museum, een abonnement op een dagblad of deelname aan een bingo.
De Meedoenbijdrage is er voor alle leeftijden!
De bijdrage is bedoeld voor alle inwoners van 0 tot 100 jaar met een laag inkomen. Inwoners met een inkomen tot 115% van de bijstandsnorm en een vermogen onder de vermogensgrens komen in aanmerking voor de bijdrage.
De Meedoenbijdrage wordt éénmaal per kalenderjaar verstrekt.
Wanneer wordt de bijdrage automatisch verstrekt?
Als je de Meedoenbijdrage in 2025 hebt ontvangen en je ontvangt ook op 1 januari 2026 een uitkering van de gemeente Waalre, wordt de bijdrage over 2026 automatisch verstrekt. Dit betekent dat je voor
1 maart 2026 een bericht (beschikking) van de gemeente ontvangt. De Meedoenbijdrage wordt dan voor 1 april 2026 op jouw bankrekening bijgeschreven. Je hoeft zelf niets te doen en je hoeft de bijdrage niet aan te vragen.
Inkomstenverklaring
Als je in 2025 een Meedoenbijdrage hebt ontvangen maar je ontvangt geen uitkering van de gemeente Waalre dan krijg je eind januari 2026 een brief van de gemeente Waalre met een inkomstenverklaring. Als je deze inkomstenverklaring voor 20 februari 2026 ingevuld en ondertekend terugstuurt en je hebt niet te veel vermogen en een inkomen van maximaal 115% van het minimum, wordt de bijdrage aan je verstrekt. Je ontvangt hierover in maart 2026 een beschikking. Als je recht hebt op de bijdrage wordt deze omstreeks 1 april 2026 op jouw bankrekening bijgeschreven. Ook nu is het niet nodig om de Meedoenbijdrage aan te vragen. Wel moet je de inkomstenverklaring terugsturen!
voor Mekaar Waalre gesloten op maandag 16 februari
Vanwege Carnaval is Goed voor Mekaar Waalre op maandag 16 februari gesloten. Vanaf dinsdag 17 februari zijn wij weer bereik-
baar op telefoonnummer 06-25762422. Wij wensen iedereen een fijne Carnaval!
Onroerendezaakbelasting 2026, hoe wordt het berekend en waar gaat het geld naartoe?
Eind februari 2026 ontvang je een belastingaanslag voor de onroerendezaakbelasting (OZB). OZB betaal je als je een woning hebt, of als je bijvoorbeeld een kantoor, winkel, school of grond bezit. De hoogte van de OZB hangt af van de waarde van je pand of grond: de WOZ-waarde. De OZB is een percentage van de WOZ-waarde. Met de opbrengst van de OZB betaalt de gemeente onder andere het onderhoud aan groen en wegen en kosten voor lokale voorzieningen zoals bijvoorbeeld de bibliotheek en welzijnswerk.
Waardepeildatum
De gemeente stelt jaarlijks de WOZ-waarde opnieuw vast. De WOZ-waarde is de prijs die de meestbiedende koper zou betalen als de onroerende zaak te koop zou staan. De gemeente gaat uit van de waarde van je pand of grond op 1 januari van het vorige belastingjaar. Deze datum heet de waardepeildatum. Dus als je in februari 2026 je WOZ-waarde binnen krijgt, is deze gebaseerd op de waarde van 1 januari 2025.
Zo wordt de WOZ-waarde bepaald
0,10365% van €500.000 ofwel €518,25 (€500.000 : 100 x 0,10365).
Kan ik zelf onderzoeken of mijn WOZ-waarde klopt? De belastingaanslag valt eind februari 2026 op de mat en/of in je digitale postbus op mijn. overheid.nl. Dan is ook de WOZ waarde van jouw pand(en) of grond(en) bekend. Ben je benieuwd naar de onderbouwing van jouw WOZ-waarde? Je kunt het taxatieverslag inzien door met je DigiD in te loggen op mijn.overheid.nl. In dit taxatieverslag staat uitgelegd hoe de WOZ-waarde is bepaald. Op de website van de Waarderingskamer is veel informatie te vinden. Op wozwaardeloket.nl kun je de WOZ-waardes zien van alle huizen in jouw gemeente of buurt. Op kadaster. nl kun je tegen betaling van een paar euro, koopsommen vinden van huizen in jouw postcodegebied in de afgelopen jaren.
Wanneer wordt de bijdrage niet automatisch verstrekt?
In alle andere situaties dan hierboven beschreven, kun je de Meedoenbijdrage 2026 aanvragen bij het Centrum voor Maatschappelijk Deelname (CMD) van de gemeente Waalre. Dit kan gedurende het gehele jaar. Je kunt terecht tijdens het inloopspreekuur SamenWijzer van het CMD. Elke dinsdag, woensdag en donderdag van 10.00 tot 12.00 uur in Medisch Centrum Aalst (MCA), Raadhuisstraat 6B, 5582 JD Waalre. Loop gerust binnen! Op woensdag is er een consulent inkomensondersteuning aanwezig. Maar ook op de andere dagen kun je met jouw vraag terecht. Daarnaast is het CMD bereikbaar via waalre.nl/cmd en telefonisch via 040-2282500 (er wordt dan een terugbelverzoek aangemaakt).
Voor meer informatie over de meedoenbijdrage kijk op: waalre.nl/inwoners-en-ondernemers/normenoverzicht-minimabeleid

Gemeentes bepalen de WOZ-waardes van onroerende zaken door een taxatie. Een gecertificeerd taxateur voert de taxatie uit. Hij kijkt naar gegevens over de grond en het gebouw, hij analyseert verkoopcijfers en hij bezoekt een aantal verkochte panden die rond de waardepeildatum 1 januari 2025 zijn verkocht. De taxateur kijkt hierbij naar verschillen in bijvoorbeeld ligging, het aantal vierkante meters van het pand en de grondoppervlakte. Er wordt geen rekening met bijvoorbeeld de hypotheek of erfpacht gehouden. Soms wordt ook gevraagd om foto’s of aanvullende informatie zodat de waarde nauwkeuriger kan worden vastgesteld. Door vergelijking van alle gegevens via een computermodel wordt uiteindelijk de waarde van de panden bepaald.
Tarieven OZB 2026
De gemeenteraad heeft op 9 december 2025 de OZB-tarieven voor 2026 vastgesteld:
• voor woningen: eigenarenbelasting 0,10365%
• voor niet-woningen: eigenarenbelasting 0,31727%
• voor niet-woningen: gebruikersbelasting 0,25521%
Rekenvoorbeeld:
Stel, je bent eigenaar van een woning met een WOZ-waarde van €500.000. De OZB is dan
Niet eens met de waarde? Bespreek het met de gemeente Heb je vragen over de totstandkoming van de WOZ-waarde of ben je het niet eens met de waarde? Dan kun je contact opnemen met de gemeente. De gemeente gaat dan binnen de bezwaartermijn met je in gesprek en beoordeelt of de waarde moet worden aangepast. Informeel contact met de gemeente over de WOZ-waarde is gratis en geeft snel duidelijkheid. Voor het aanvragen van informeel contact met de gemeente kun je gebruik maken van het formulier op de website. De gemeente neemt dan binnen 1 week contact met je op. Mocht je het na dit contact met de gemeente niet eens zijn met de WOZ-waarde, dan kun je alsnog formeel bezwaar indienen, binnen 6 weken na de datum op de OZB-aanslag.
Indienen van een formeel bezwaar
Je kunt binnen 6 weken na de datum van de OZB-aanslag formeel bezwaar maken tegen de WOZ-waarde. Na deze datum is geen bezwaar meer mogelijk en staat de WOZ-waarde vast. Hoe je bezwaar kunt maken, staat op je belastingaanslag aangegeven. Zelf bezwaar maken bij de gemeente tegen de WOZ-waarde van je woning is gratis!
Verkoop of verhuizing Onroerendezaakbelasting betaal je voor het hele jaar. Verkopen of verhuizen verandert niets aan de betalingsplicht. Bij verkoop van een pand wordt de OZB voor het lopende jaar via de notaris met de nieuwe eigenaar verrekend.

Op dinsdag 3 februari 2026
voerde het Kempen Interventie Team (KIT) (gemeente, politie, Omgevingsdienst en Veiligheidsregio) een onaangekondigde bestuurlijke controle uit bij een hotel in Waalre.
Controle
De controle bij het hotel was gericht op naleving van bouwvoorschriften en het gebruik van het pand in overeenstemming met het omgevingsplan. Tijdens deze controle is vastgesteld dat enkele onderdelen niet voldoen aan de geldende bouwvoorschriften. In overleg met de eigenaar worden deze punten hersteld.
politie, Omgevingsdienst en Veiligheidsregio. De Kempengemeenten zijn de gemeente Veldhoven, Best, Oirschot, Waalre, Reusel-De Mierden, Bladel, Eersel en Bergeijk. Dit team controleert regelmatig locaties waarbij het vermoeden bestaat dat er sprake is van het niet voldoen aan wet- en regelgeving of van andere misstanden. Zoals (illegale) bewoning, strijdig gebruik van het pand, brandveiligheid, inschrijving in de Basisregistratie Personen (BRP), prostitutie, mensenhandel, drugs.

AANKOMENDE VERGADERINGEN
VAN DE GEMEENTERAAD
Melden
Kempen Interventie Team
Het Kempen Interventie Team is een samenwerkingsverband tussen de acht Kempengemeenten,
tact op met de griffie, via griffie@waalre.nl of 040 2282500.
Signalen of vermoedens kun je altijd anoniem melden bij Meld Misdaad Anoniem via 0800-7000, kijk ook op meldmisdaadanoniem. nl. Je kan het melden bij het politieteam in jouw buurt, telefoon: 0900-8844, of via de gemeente: handhaving@waalre.nl
Dinsdag 17 februari geen vergadering in verband met de carnavalsvakantie.
Dinsdag 24 februari oordeelsvormende bijeenkomst (mening vormen).
De raad vergadert in het Huis van Waalre. U bent van harte welkom bij de vergaderingen. Ook kunt u live meekijken via waalre.raadsinformatie.nl. De vergaderingen starten om 19.30 uur. Voor de onderwerpen die oordeelsvormend op de agenda staan, geldt spreekrecht. Neem hiervoor op tijd con-
WAALRE.NL/GEMEENTERAAD
Agenda’s van raadsbijeenkomsten en de documenten die erbij horen vindt u op de website van de gemeenteraad. Via de link vergaderingen vindt u de agenda’s die er zijn.
• toegang tot vergaderdata, -stukken en –verslagen • informatie over spreekrecht
• hoe kunt u invloed uitoefenen op het beleid? • contactadressen van fracties en raadsleden
en uitbreiden van bestaand kantoor
De gemeente Waalre maakt officiële bekendmakingen digitaal bekend in het Gemeenteblad op www.officiëlebekendmakingen.nl. Hieronder plaatsen we enkel verkorte berichten als service. De digitale versie is rechtsgeldig. Daar lees je ook of er inzage mogelijk is en welke bezwaar- en/of beroepsprocedures je kunt volgen.
De bekendmakingen zijn ook te vinden via www.waalre.nl/bekendmakingen. Op www.overheid.nl/berichten-over-uw-buurt kun je je aanmelden voor de e-mailservice met berichten over jouw buurt.
Aangevraagde omgevingsvergunningen: Brabantialaan 30: het verbouwen
scheepswerkplaats, 4 Midden en Kleinbedrijf (afk.), 6 (afk.), 12 inwisseling, 14 peddel, 16 ziener, oude maat, 22 Business Software Alliance uitheems café, 27 traag, 29 opgewekt, 31 hoeveelheid, 36 morsdoekje, 38 appartement, persoonlijk voonaamwoord, 41 uitwisseling, beeltenis, 49 traject, 51 bergplaats, 52 voornamelijk (afk.), 56 in geheime zitting (afk.), 62 grappige filmgebeurtenis, 63 kasteel, naam van, 70 straat (Fr.), 71 vertraging Nederlandse Aardolie Maatschappij (afk.). besmet, 3 zendgemachtigde, 4 gerecht, 5 klap, 10 visagie, 11 waterdier, 13 vliegende aannemelijk bod (afk.), 18 naar de kant, 20 visnet, tijdelijk kader (afk.), 24 doorgangsheffing, redelijkheid, 30 briefaanhef, 32 uitgestotene, 35 43 ten name van (afk.), 44 onder andere schenking, 49 spon, 50 meisjesnaam, 52 bladzijde, Mountain Bike (afk.), 62 stuf, 63 Verenigde mager, 66 slaghout, 67 standaard voor mobiele
GEMEENTE WAALRE
Postbus 10.000
5580 GA Waalre (040) 2282500
gemeente@waalre.nl
www.waalre.nl
X : @Waalregemeente
facebook : facebook.com/GemeenteWaalre
Instagram : @gemeentewaalre
LinkedIn : Gemeente Waalre
BEZOEKADRES
Koningin Julianalaan 19 5582 JV Waalre
COLLEGE VAN B&W EN RAAD
Koningin Julianalaan 19 5582 JV Waalre
Voor een afspraak neemt u contact op met het bestuurssecretariaat, (040) 2282500.
Raadhuisstraat 8: het verbouwen van een bedrijfspand
Verlenging beslistermijn:
15 muntstuk, hoeveelheid, 21 schimpscheut, 27 32 kleren die spreekwijze, barbaar, 40 45 zangnoot, toetsing, 50 twee punten, 54 gebruikelijke wijze aanwijzend toespraak, 6 10 kweker, 17 geld, 19 25 moeite, 26 geeuw, 32 slogan, leeuwenjong, markt, 44 grond, voor tijdelijk 51 pluspunt, Uit Leende
Actualisatie reglement gemeenteraad
Velddreef 24: het plaatsen van een nieuw dak
Bolksheuvel 56: het vervangen van bestaand hekwerk
Eindhovenseweg 4: het vergroten van een zolder
Resedalaan 9: het plaatsen van een bijgebouwtje
OPENINGSTIJDEN
Een afspraak maken met loket
Burgerzaken kan op:
Ma t/m vrij van 8.30 - 12.30 uur Do van 8.30 - 19.30 uur
TELEFONISCHE BEREIKBAARHEID
Ma t/m do van 8.30 - 17.00 uur Vrijdag van 8.30 - 12.30 uur
Horizontaal: 1 aangenaam, 7 eerste vrouw, 10 beschoeide waterkant, 13 garde, 14 uitroep, 15 witgoud, 16 koptelefoon, 18 land- en tuinbouworganisatie (afk.), 19 dwingende vraag, 20 soort, 21 term uit de Indische keuken, 23 Griekse kaas, 25 droogoven, 26 tournee, 27 albinobunzing, 29 snavel, 30 kledingstuk, 33 verpleegster, 36 plaats in Noord-Brabant, 37 vreemde munt, 38 stek, 39 klad, 42 plaats in Gelderland, 43 projectieplaatje, 44 plaaggeest, 45 tweewieler, 47 rivier bij Baarn, 48 godsdienstoefening, 49 dringend verzoek, 50 doorsijpeling van water onder de dijk door, 52 jongensnaam, 53 witte plek op het voorhoofd van een paard, 57 uitgezette aslijn, 59 reeks, 60 eiland (Fr.), 61 in afschrift aan (afk.), 62 bravoure, 66 drukfout, 67 mannelijk dier, 68 achtervoegsel, 69 weefsel met mazen, 70 een zekere, 71 onwetendheid.
Verticaal: 1 toets, 2 communist, 3 rangtelwoord, 4 dicht, 5 mager, 6 graan, 7 heldenroman, 8 insect, 9 strategie, 10 woekering, 11 tegen, 12 land in Azië, 17 pedant, 22 voegwoord, 24 mondblaartje, 25 fijne nevel, 26 onderhoud, 28 record (afk.), 29 koeienziekte, 31 regelmaat, 32 deel van de hals, 33 moraal, 34 vereniging, 35 moederkaart, 36 Optical Character Recognition (afk.), 40 Nederlands astmafonds (afk.), 41 rust, 46 spinsel, 48 ledigheid, 49 soort restaurant, 51 toilet, 52 stad in Brazilië, 54 slingerplant, 55 noords zoogdier, 56 aanhangers van een geestelijke stroming buiten de reguliere kerk, 57 telwoord, 58 malloot, 59 Europese hoofdstad, 63 stormloop, 64 vreemde munt, 65 klein kind.
week 26: Verberne uit Deurne
Den Hof 18: het vervangen van bestaande handelsreclame (nabij) Malvalaan & Burgemeester Mollaan: het oprichten van een tijdelijk antenne opstelpunt Vodafone 18251 Aalst
Nassaustraat 1: het splitsen van een woning in twee appartementen
Eindhovenseweg 67: het plaatsen van een keerwand
CENTRUM VOOR MAATSCHAPPELIJKE DEELNAME (040) 2282500 cmd@waalre.nl www.waalre.nl/cmd
KLACHT OF MELDING Voor het doen van een melding of het indienen van een klacht ga naar www.waalre.nl/meldingdoen
Reglement van orde voor de vergaderingen en andere werkzaamheden aangaande de gemeenteraad van Waalre 2026 –vastgesteld
Winnaar van vorige week: Karin Wisman Uit Mierlo Proficiat!
Winwoord: SUPERSCRIPT
moet bij ons binnen zijn vóór maandag 9.00 uur: puzzel@dasmediacentrum.nl specialiteiten restaurant IRODION, Bogardeind 17, 5664 EA Geldrop
Uw oplossing op een briefkaart of via de e-mail, met naam- en adresgegevens moet bij ons binnen zijn vóór maandag 9.00 uur: Das Mediacentrum, Laan ten Roode 71e, 5711GB Someren, puzzel@dasmediacentrum.nl De winnaars krijgen een GRATIS diner voor 2 personen te besteden bij Grieks specialiteiten restaurant IRODION, Bogardeind 17,
Geldrop
GEMEENTENIEUWS Het gemeentenieuws vindt u ook op www.waalre.nl. De gemeentelijke pagina’s staan onder redactie van Team Communicatie.
Stedenbouwkundige visie
Ekenrooi Zuid
Aalst Waalre Belang heeft op 3 februari jl. niet ingestemd met de stedenbouwkundige visie Ekenrooi Zuid.
Waarom niet? De partij vindt de bouwkundige visie van Ekenrooi-Zuid op zich bijzonder goed. Het is een open plan met veel groen. Woningen die ruimtelijk zijn ingepland tussen het kerkdorp Aalst en het bosgebied. In het plan is een ruime mogelijkheid opgenomen voor de volkstuinen in een parkachtige zetting. Ook is er in principe ruimte voor CPO (Collectief Particulier Opdrachtgeverschap).
Aalst Waalre Belang is echter geschrokken van het ontbreken van een adequate ontsluiting van de nieuwe woonwijk. Met als gevolg dat het extra verkeer een weg moet zoeken over de bestaande woonstraten links en rechts van de Tongelreep. Gevreesd wordt dat het verkeer via de woonstraten waaronder de Goudbergstraat, Anna Paulownalaan, of Ekenrooisestraat, van en naar de Eindhovenseweg gaat. Ook verkeer via de Pastoor van der Heijdenstraat naar de Sophiastraat ligt voor de hand.
Deze wijze van ontsluiting voldoet, wat AWB betreft, niet aan de voorwaarde voor een adequate ontsluiting van de wijk Ekenrooi-Zuid. Deze noord-zuid bewegingen van het autoverkeer doorkruisen de oost-west verkeersbewegingen van met name het langzaam verkeer van schoolgaande kinderen en voetgangers van en naar de basisscholen en winkelcentrum Den Hof. AWB voorziet dan ook veel potentiële gevaarlijke situaties door het ontbreken van een adequate ontsluiting.
Aalst Waalre Belang heeft steeds gehamerd op een adequate ontsluiting. Nu deze ontbreekt heeft AWB met pijn in het hart tegen dit overigens mooie bouwplan moeten stemmen. Dit te meer omdat een door de fracties van de VVD en ZW14 ingediende motie om de mogelijkheid voor een toekomstige extra verkeersontsluiting via een weg buitenom open te houden door de raad niet werd gesteund.
Wij hebben deze motie wel gesteund omdat wij het van belang achten dat er geen maatregelen genomen worden die, wanneer in de toekomst blijkt dat de huidige wijze van ontsluiting tot problemen leidt, de keuze voor de aanleg van een alternatieve ontsluiting belemmeren.
Erwin Rutten, raadslid fractie Aalst Waalre Belang
WAALRE - In Waalre aan Molenstraat 5 start binnenkort de bouw van Villa De Weverij. De Zorgvilla komt tot stand door een samenwerking tussen Arlo (projectontwikkelaar & eigenaar) en Zorggroep De Laren (exploitant & huurder). Villa De Weverij wordt gebouwd op de locatie van het voormalig Walra terrein. Het ontwerp van de villa is van Bureau 070, de aannemer is Aannemersbedrijf Van Rijswijck uit Eindhoven.
De naam Villa De Weverij is bewust gekozen en verweven met de geschiedenis van deze locatie.
Aan de Molenstraat werd jarenlang gebouwd aan het merk Walra, met een confectieatelier waar kwalitatief hoogwaardig linnengoed werd vervaardigd. Linnen en katoen, gemaakt voor het dagelijks leven en bedoeld om lang mee te gaan: voor een levenslange liefde (oud-reclameslogan van Walra).
De daadwerkelijke weverij bevond zich achter de panden aan de Markt, maar juist aan de Molenstraat kreeg Walra zijn gezicht en reputatie. Daar waar ontwikkeling, vakmanschap en kwaliteit samen kwamen, wat voor velen nog altijd herkenning oproept. Die geschiedenis vindt z’n weerklank in de naam van de nieuwe bestemming. Een originele steen uit het voormalige confectieatelier krijgt een plek in de gevel




als blijvende verwijzing naar de historie van de locatie. Villa De Weverij wordt een kleinschalige woonomgeving waar levensverhalen samenkomen en aandacht wordt verweven in het dagelijks leven. Met respect voor wat hier was en ruimte voor nieuwe hoofdstukken.
Arlo is trots op deze locatie een zorgvilla te mogen ontwikkelen met een bijzonder zorgconcept. De ontwikkeling sluit aan bij de overtuiging dat gebouwen meer zijn dan stenen alleen. Met respect voor de geschiedenis van de locatie en oog voor de toekomst realiseert Arlo een duurzame en warme woonomgeving waar zorg
en wonen op een vanzelfsprekende manier samenkomen. De samenwerking met Zorggroep De Laren past daarbij naadloos binnen de langetermijnvisie van Arlo, waarin kwaliteit, betrokkenheid en persoonlijke aandacht centraal staan.
Voor Zorggroep De Laren is dit de achtste zorgvilla in Nederland waar zij hoogwaardig wooncomfort in combinatie met professionele 24-uurszorg en gastvrije service realiseert. Bewoners behouden de regie over hun leven en wonen zo zelfstandig mogelijk. (Echt)paren kunnen er samenwonen. Naar verwachting zullen de eerste bewoners in mei 2027 hun
appartement kunnen betrekken.
Indeling zorgvilla
De stijlvolle zorgvilla krijgt 24 onzelfstandige zorgappartementen variërend in grootte van circa 60 tot 90 m2. Alle met aparte slaapkamer(s), badkamer, pantry en een eigen buiten, terras of balkon. De toekomstige bewoners van Villa De Weverij bepalen zelf hoe hun stijlvol gestoffeerde appartement wordt ingericht. Elk appartement heeft zijn eigen voordeur onder het gemeenschappelijke dak van de villa. Het gebouw wordt volledig rolstoeltoegankelijk en beschikt uiteraard over een lift. Rondom de villa komt een wandelpad in de prachtig aangelegde besloten tuin met terras. Ook komen er een gezamenlijke serre, eet- en zitkamer met vleugel. Senioren met een zorgbehoefte komen in aanmerking voor wonen in Villa De Weverij als ze in het bezit zijn van een Wlz-indicatie van het Centrum Indicatiestelling Zorg.
Informatieavond
Voor geïnteresseerden (toekomstige bewoners, hun naasten, toekomstige medewerkers, buurtbewoners) is er een informatiebijeenkomst op: woensdag 8 april van 19.00 tot 21.00 uur in het Huis van Waalre, Koningin Julianalaan 19, Waalre. Meer informatie via mail: contact@zorggroepdelaren. nl
WAALRE - Het Klooster in Waalre is maandag 16 februari het decor van ’t Keiengats Muziekskesbal. Vanaf 19.30 uur is iedereen welkom voor een avond vol livemuziek en Brabantse gezelligheid.
De Keiendweilers en Keienkrakers zorgen elk jaar voor een vol programma waarin de beste dweil- en blaaskapellen het podium betreden. De toegang is gratis.
Maandag 16 februari betreden de volgende kapellen het podium: P.I.A.S.; Fluttetutters; Keiendweilers; Blue Band; Black Wooow; Keienkrakers; Kwelpiepers; Stadshofkapel de Een-
dracht; Blusswerruk; Pompzwengels en Verrekusbloas.
Het Keiengats Muziekskesbal blijft een laagdrempelig evenement waar jong en oud welkom is. Met een rijk gevuld programma en een brede line-up belooft de editie van 2026 opnieuw een van de hoogtepunten van het carnavalsseizoen te worden.
Meer informatie
Blijf op de hoogte van de meeste actuele stand van zaken via de Facebookpagina van het Keiengats Muziekskesbal
https://www.facebook.com/KeiengatsMuziekskesbal


Volle bak, gezellig muziek en heel veel sfeer bij het Keiengats Muziekskesbal (Foto: Jacqueline van de Weijer)


Nellie is een prachtige, slanke jonge poes met een opvallende wit-zwarte vacht en een lief, sociaal karakter. Ze geniet zichtbaar van aandacht en knuffels, maar heeft ook haar eigen grenzen en ze geeft dat ook aan. Nellie is dol op spelen en actief bezig zijn. Ze vindt bijna alle soorten speelgoed leuk, van hengels en muisjes tot ballenbanen, zolang ze haar energie kwijt kan en lekker kan ontdekken. Ze is nieuwsgierig en ondernemend en verkent graag haar omgeving. Andere katten maken haar onzeker; daarom wordt Nellie het
liefst in een huishouden zonder andere huisdieren geplaatst. Helaas is Nellie door haar oorspronkelijke eigenaar niet opgehaald. Daarom is zij nu op zoek naar een nieuw, liefdevol thuis waar ze helemaal zichzelf kan zijn. Haar ideale huis is een rustig en stabiel gezin waar ze de aandacht krijgt die ze verdient. Een (afgeschermde) tuin is een mooie extra.
Kun jij Nellie een warm en blijvend thuis geven? Maak snel kennis met haar. https://rozeindhoven.nl/asieldieren
REGIO – Het oogcafé is een plek waar mensen met een oogaandoening of zichtprobleem elkaar kunnen ontmoeten en ervaringen kunnen delen. Regelmatig staat het oogcafé in het teken van een bepaald thema.
Het Oogcafé is weer geopend op vrijdag 20 februari in de bibliotheek in De Hofnar in Valkenswaard. Inloop vanaf 13.30 uur, aanvang is 14.00 uur en de sluiting is rond 16.00 uur.
Het thema voor de maand februari 2026: ‘De Notaris vertelt’: De heer R. Smeets (oud-notaris) van Willems en Smeets Notarissen bespreekt diverse zaken, zoals oa het levenstestament, en beantwoordt graag jullie vragen. Heb je
al een vraag voor hem, geef het dan alvast door aan oogcafevalkenswaard@gmail.com Na afloop is er gezellig napraten. De toegang is gratis. Vooraf aanmelden is niet verplicht maar wordt op prijs gesteld. Dit kan via: oogcafevalkenswaard@ gmail.com
Ken je iemand met een visuele beperking? Informeer hem/haar over dit initiatief!

VALKENSWAARD – Het Taalcafé is een gezellige en informele bijeenkomst waar de deelnemers samen met anderen de Nederlandse taal kunnen oefenen. Of je nu net begint met Nederlands leren of al wat verder bent, iedereen is welkom.
Het Taalcafé is op maandagavond en woensdagochtend.
De bijeenkomst op maandag is van 19.30 tot 21.30 uur. Hiervoor geldt: vooraf aanmelden is verplicht -De bijeenkomst op woensdag heeft een vrije inloop en is 10.15 tot 12.00 uur.
De bijeenkomsten vinden plaats in Valkenswaard bij Cordaad Welzijn in de Hofnar 12.
Meld je aan als Taalcoach Naast het Taalcafé zoeken wij ook enthousiaste taalcoaches die anderstaligen willen helpen bij het leren van de Nederlandse taal. Als taalcoach kun je een verschil maken voor iemand die de taal wil leren, en samen werken aan het vergroten van hun zelfvertrouwen en vaardigheden.
Neem bij interesse contact op met Belinda Brinkman van Cordaad Welzijn om meer te weten te komen over de mogelijkheden! Bereikbaar op tel.nr.: 06-22 33 84 23 of via mail: belindabrinkman@ cordaadwelzijn.nl
RIETHOVEN – De carnavalshoogheden van CV De Bremspoersen uit Riethoven en AWC De Keien uit Waalre ontmoeten elkaar vrijdagavond traditiegetrouw aan de oevers van de Dommel bij De Volmolen. De jarenlange vriendschapsbanden tussen de beide verenigingen worden dan opnieuw bevestigd door elkaar op ludieke wijze de hand te schudden. Dit jaar wordt een bijzondere carnavalsmijlpaal gevierd. De handreiking over de Dommel vindt voor 33e keer (3x11) plaats.
Door Roy de Leijer
De verbindende activiteit is uitgegroeid tot een niet meer weg te denken traditie bij veel carnavalsvierders in Waalre en Riethoven. “Overdag zijn we al op pad, maar je kan dit zien als de start van het carnavalsweekeinde”, zegt Jan van der Vleuten, voorzitter van CV De Bremspoersen. “Carnaval is een echt verbroederingsfeest. We komen ieder jaar een paar keer bij elkaar op bezoek”, vult collega-voorzitter Bart van de Weijer van De Keien aan.
Van der Vleuten vertelt dat de eerste editie van de ‘handreiking’ in 1993 plaatsvond. Het initiatief werd destijds genomen door twee carnavalsvierders uit beide dorpen, namelijk Cor van Grootel van De Bremspoersen en Hein Velter van De Keien. Het handen schudden vindt plaats
REGIO – De parochie H. Willibrord (Aalst-Waalre-Valkenswaard) nodigt belangstellenden uit om op zaterdag 14 maart mee op bedevaart te gaan naar Smakt en Kevelaer. Het belooft een mooie dag te worden van ontmoeting en bezinning.
De bus vertrekt om 09.00u en heeft opstapplaatsen in Valkenswaard en Aalst.
In de ochtend komen de bedevaartgangers aan in Smakt voor een bezoek aan de Jozefkapel en koffie met gebak.
Rond de middag is de aankomst in Kevelaer (Duitsland). Hier kunnen de deelnemers op eigen gelegenheid lunchen, wonen zij de H. Mis bij, brengen een bezoek
aan de genadekapel en hebben wat vrije tijd.
Rond 17:30 uur is de bus weer terug in Valkenswaard en Aalst. Aanmelden graag uiterlijk 12 februari per mail naar parochiecentrum@willibrord-valkenswaard.nl of schriftelijk naar de pastorie van Valkenswaard, Aalst of Waalre. Kosten voor deelname bedragen 15 euro per persoon, kinderen tot 12 jaar betalen 7,50 euro.


bij de Dommel, de symbolische grens tussen Riethoven en Waalre. Dat gebeurt op ludieke wijze. De prinsen van beide verenigingen reiken elkaar vanaf de oevers van het riviertje bij café-camping De Volmolen letterlijk de hand. “Dat gebeurt met grote handen op stokken. Het is altijd heel leuk om te zien”, aldus Van de Weijer.
Dit jaar schudden prins Capreolus van De Keien en Roel d’un Urste van De Bremspoersen elkaar de hand. De prinsen krijgen daarbij hulp van andere hoogheden van beide carnavalsverenigingen. “Vaak zorgen de prinsen voor een ludieke actie, maar dat is meestal een verrassing”, zegt
Van de Weijer. Dit jaar krijgt het verbroederingsmoment vanwege het jubileum een extra feestelijk tintje. Van der Vleuten: “We besteden er daarom meer aandacht aan, bijvoorbeeld via social media.”
Belangstellenden kunnen de bijzondere carnavalsmijlpaal vrijdag vanaf 19.11 uur meebeleven aan de oevers van de Dommel. Het geheel wordt muzikaal omlijst door blaaskapellen. Na de handreiking wordt bij De Volmolen traditiegetrouw het eerste vat Dommelsch Bier aangeslagen door Joost van Rens, Opperpintenwipper van CV De Pintenwippers uit Dommelen, en de beide prinsen.
Vlaamse band ‘Het Zesde Metaal’ in Theater De Hofnar

VALKENSWAARD – Met tijdloze nummers en gelauwerde albums heeft de Het Zesde Metaal, rond frontman Wannes Cappelle zich stevig verankerd in het muzieklandschap. Op donderdag 26 februari staat de Vlaamse band op het podium van Theater De Hofnar.
Dit voorjaar trekt frontman Wannes Cappelle langs de Nederlandse theaters, geflankeerd door cellist Frans Grapperhaus. Het duo brengt met Even tussen ons een rijke selectie uit het oeuvre van Het Zesde Metaal. Bij een theaterconcert van Het Zesde Metaal krijg je niet alleen de songs in al hun puurheid te horen. Wannes Cappelle houdt zijn publiek tussen de liedjes door bij de les met sappige verhalen en beschouwingen die zijn verleden als cabaretier verraden.
Begin 2024 verscheen het zesde album ‘Het langste jaar’ dat samen met het vorige album ‘Skepsels’ ook de doorbraak van Het Zesde Metaal in Nederland betekende.
Info & kaarten
De kaartverkoopbalie is geopend op maandag t/m vrrijdag van 13.00 tot 17.00 uur (040-2074010) of mail naar kaartverkoop@hofnar.nl Kijk voor meer informatie op www.hofnar.nl

1 Kyara Verstappen
2 Han Julicher
3 Michiel Roelofs
4 Saskia Harks
5 Roos Reurings 1




D66 Waalre staat midden in de samenleving: wij wonen, sporten en ondernemen hier. We weten niet alles, maar luisteren wél naar wat er speelt. Het gaat om ons allemaal. We investeren in betaalbare woningen, veilige fietsroutes en het groene karakter van Waalre.
Wij staan voor gelijke kansen voor iedereen in Waalre – met goede scholen, toegankelijke zorg en levendige ontmoetingsplekken.
Wij denken in mogelijkheden, voor en mét inwoners en ondernemers, om iedereen in Waalre vooruit te helpen. Samen maken we ons dorp elke dag een stukje mooier.

1 2 3 4 5
Een fijn thuis voor ons allemaal
We versnellen de bouw van duurzame en betaalbare huizen.
Langzaam verkeer op 1, jong en oud veilig vooruit
We geven fietsen en wandelen meer aandacht, met veilige routes.
Iedereen telt en doet mee
Gelijke kansen, met hulp waar nodig om zelf vooruit te komen.
Fijn leven in een gezonde, groene omgeving
We geven Waalre meer groen en ruimte voor bewegen en sporten.
Een sterke buurt voor iedereen
We zorgen voor onderwijs, zorg en voorzieningen dichtbij huis.








Weken van uitgave: week 7, 21, 37 en 45. Totale oplage: 85.300 ex.

/


16 - 38 uur per week
Dagen / tijden / locatie in overleg
Gezellige werksfeer
20% korting op je aankoop
Uurloon
€17,82 per uur*
(*incl. 8% vakantietoeslag en 10% vakantiedagen)
Interesse? Stuur je sollicitatie met CV naar sollicitatie@bakkerijdevocht.nl

Woensdag 10 september 2025
Eindhoven, Waalre, Nuenen, Geldrop, Best, Son, Maarheeze, Deurne, Valkenswaard, Gemert, Leende www.bakkerijdevocht.nl


Vacature Lasser
Van Rijssel is een gespecialiseerd carrosseriebedrijf dat op maat gemaakte opbouwen voor vrachtwagens produceert van hoge kwaliteit, meestal in combinatie met een HMF of Penz autolaadkraan.
Wij zijn op zoek naar een enthousiaste lasser. Dit is hoofdzakelijk aluminium en staal. Wij bieden stabiliteit en volop mogelijkheden voor persoonlijke ontwikkeling.
Taken:
- Lassen MIG / MAG, zowel aluminium als staal
- Mogelijkheid om je te ontwikkelen en een lasdiploma te behalen
- Samenwerken in teamverband.
- Werken in onze ultra moderne werkplaats die van alle nieuwe technieken is voorzien.
Van Rijssel Carrosseriebedrijf BV is een hechte organisatie waar we hard werken, verantwoordelijkheid nemen en plezier hebben in wat we doen. Als dit jou aanspreekt en deze vacature bij jou past, stuur dan een mail met daarin je CV naar info@van-rijssel.nl
We kijken uit naar je reactie !
Met name voor jongeren die hun eerste stappen zetten op de arbeidsmarkt, zijn stages en traineeships vaak een belangrijke kans. Het zijn momenten waarop kennis uit de opleiding samenkomt met de praktijk. Wat je op school leert, krijgt pas echt betekenis wanneer je het toepast in een bedrijf.
De overstap van studie naar werk kan groot zijn, en juist daarom bieden deze trajecten een veilige manier om te wennen én te groeien. Een stage is vaak de eerste kennismaking met het werkveld. Studenten leren hoe hun vak er in de praktijk uitziet en ontdekken wat er allemaal bij hoort. Ze ervaren hoe het is om samen te werken, hoe ze omgaan met verantwoordelijkheden en welke rol ze zelf kunnen spelen in een team. Voor bedrijven heeft dit ook voordelen: stagiairs brengen vaak nieuwe ideeën mee en kijken met een frisse blik naar bestaande processen. Niet zelden wordt een goede stage beloond met een baan, waardoor het een win-win situatie is.
Een traineeship richt zich meestal op jonge mensen die net hun diploma hebben gehaald. Ze zijn klaar om te gaan werken, maar weten soms nog niet precies welke richting het beste bij hen past. In een traineeship maken zij kennis met verschillende taken en afdelingen binnen een organisatie. Zo ontdekken ze waar hun talent ligt en waar ze energie van krijgen. Meest-

al duurt zo’n traject een of twee jaar. Na afloop hebben trainees niet alleen meer vakkennis, maar ook een duidelijker beeld van hun toekomst en hun plek binnen het bedrijf.
Stages en traineeships helpen jonge mensen ook om een netwerk op te bouwen. Het contact met begeleiders, collega’s en ma-
nagers kan later deuren openen naar een vast contract of nieuwe kansen. Voor bedrijven is het een manier om te laten zien dat ze aantrekkelijk zijn als werkgever. Niet alleen door salaris of voorwaarden, maar vooral door de begeleiding en de mogelijkheden die ze jongeren bieden. Opleidingen weten dat praktijkervaring belangrijk
is om studenten voor te bereiden op werk. Werkgevers merken dat investeren in jonge mensen loont. Een stagiair of trainee die zich goed begeleid voelt, blijft vaak langer en is meer betrokken bij het bedrijf. Daarnaast krijgt een organisatie die bekendstaat als een goede plek voor starters vanzelf meer interesse van nieuw talent.




We zijn op zoek naar:
Servicemonteur grondverzetmachines
Opbouwmonteur grondverzetmachines
Mechanisch monteur rupsmobiele voertuigen
Solliciteer hier werkenbijverhoeven.com

Bezoek ons tijdens de Open Bedrijvendag op zaterdag 28 maart!






Je hebt er alles voor gegeven. Gestudeerd, gesolliciteerd, en je hebt je uiterste best gedaan toen je de baan eenmaal had. Maar langzaam dringt het besef door; dit is niet wat ik wil. Wat nu?
Wat je zeker niet moet doen is wanhopen. Oké, dit is misschien niet wat je verwacht had, en ja, het is spannend om een nieuw pad in te slaan, maar besef om te beginnen dat de tijd die je aan dit vak hebt besteed geen verloren tijd is. Je hebt dingen geleerd, je hebt ervaring opgedaan en niet in de laatste plaats, je hebt jezelf beter leren kennen, en dat kan je helpen bij het maken van nieuwe beslissingen.
Onderzoek
Oké. Het valt dus tegen. Maar waar ligt dat precies aan? Neem om te beginnen de tijd om te begrijpen waarom je droombaan tegenvalt. Is het vanwege de werkomgeving, de bedrijfscultuur, de taken die je moet uitvoeren, het gebrek aan groeimogelijkheden, of iets anders? Identificeer specifiek wat niet aan je verwachtingen voldoet. Als de problemen gerelateerd zijn aan de werkomgeving, taken of verwachtingen, overweeg dan om het gesprek aan te gaan met je leidinggevende. Soms kunnen aanpassingen worden gemaakt om de situatie te verbeteren, zoals het herschikken van taken, het bieden van extra training of het veranderen van teams. En hoewel je baan misschien niet aan al je verwach-

tingen voldoet, zijn er waarschijnlijk nog steeds positieve aspecten aan de baan. Probeer je te concentreren op wat wel goed gaat en waar je blij van wordt in je werk. Dit kan je helpen om gemotiveerd te blijven en een meer evenwichtige kijk te behouden.
Zoeken met behoud van het goede Als de situatie niet verbetert en je merkt
dat je ongelukkig blijft in je baan, overweeg dan om oplossingen te zoeken. Dit kan variëren van het zoeken naar interne overplaatsingsmogelijkheden binnen het bedrijf tot het actief zoeken naar nieuwe kansen buiten de organisatie. Bij het vinden van een nieuwe baan kun je al die aspecten die eerder genoemd zijn gebruiken. Je weet nu immers waar je goed in bent en waarin niet, wat je blij
maakt en wat niet. Met een beroepskeuzetest of een coach kun je kijken welke banen er zijn die de fijne factoren van je voormalige droombaan combineren. Wees niet bang om nieuwe paden te bewandelen. Wellicht kun je een keer stage ergens lopen of kun je via vrijwilligerswerk een eerste ervaring opdoen. (zie elders in deze krant.) Zo voorkom je een nieuwe teleurstelling.


Jongeren van nu betreden een heel andere arbeidsmarkt dan oudere generaties. En ze doen dat ook op een andere manier. Ze combineren veel meer zaken met elkaar. Opleiding, sport, en ja, ook banen.
Zo kiezen sommige jongeren ervoor om meerdere kleine banen tegelijk te doen. Bijbanen tijdens de studie en combinaties van deeltijdwerk, flexbanen en freelance opdrachten. Voor hen biedt het flexibiliteit, ervaring en een kans om hun netwerk snel uit te breiden. Werkgevers zien dit en veel van hen waarderen dat. Op hun beurt willen ze dat vaak ook faciliteren. Bedrijven zijn vaak flexibel, vooral als ze weten dat jongeren meerdere verplichtingen hebben. En dat vinden ze best, zolang beide partijen maar duidelijk communiceren wat er kan, en bijvoorbeeld wanneer je beschikbaar bent. Het vraagt om vertrouwen bij beide partijen. Ook voor wie niet jong meer is, maar (ander) werk zoekt, valt hier iets van te leren. Meerdere kleine banen kunnen een opstap zijn naar een vastere positie. Vaak leidt een combinatie van banen tot nieuwe kansen via contacten en aanbevelingen. Het combineren van banen vraagt wel discipline. Je moet goed plannen, prioriteiten stellen en communiceren met je werkgever. Het is belangrijk dat de ene baan niet lijdt onder de andere. Is het dan alleen maar rozengeur en ma-

neschijn? Nee. Een belangrijk nadeel is de onzekerheid. Met meerdere kleine banen is het inkomen vaak wisselend. Uren kunnen wegvallen en contracten zijn meestal tijdelijk of flexibel. Dat maakt het lastig om financiële zekerheid op te bouwen of plannen te maken, zoals op jezelf wonen of sparen. Ook sociale zekerheid, zoals
pensioenopbouw of doorbetaling bij ziekte, is vaak beperkt of versnipperd. Daarnaast kan de belasting hoog zijn. Het combineren van verschillende werkgevers vraagt veel organisatie en energie. Jongeren moeten steeds schakelen tussen taken, werksferen en verwachtingen. Ook de ontwikkeling kan een knelpunt zijn. Klei-
ne banen bieden niet altijd doorgroeimogelijkheden. Werkgevers investeren bovendien minder snel in opleiding of begeleiding als iemand maar een paar uur werkt of tijdelijk beschikbaar is. Een laatste gevaar is dat je in tijdelijke banen ‘blijft hangen’ en zo dus nooit stabiliteit bereikt.
WIJ ZIJN OP ZOEK NAAR EEN (JUNIOR) FINANCIEEL MEDEWERKER
Ons bedrijf en filosofie:
Vd Winkel & Partners te Geldrop is gespecialiseerd in advies op maat, administratieve dienstverlening, belastingadvies, loonadministratie en begeleiden bij financieringsaanvragen voor voornamelijk het midden – en kleinbedrijf.
Persoonlijk en regelmatig cliëntencontact staat bij ons hoog in het vaandel, zodat wij goed op de hoogte blijven van de wensen van de cliënt. De kwaliteit van onze dienstverlening proberen wij steeds zoveel mogelijk te optimaliseren.
Functieomschrijving:
Je hebt affiniteit met de financiële sector, bent leergierig en gedreven. Met oog voor detail weet jij financiële administraties nauwkeurig te verwerken en eigen te maken. Hierbij word je ondersteund door ervaren en deskundige collega’s en rapporteer je aan relatiebeheerders.
Kwaliteit staat bij jou hoog in het vaandel, je bent klantvriendelijk, sociaalvaardig en collegiaal.
Functie eisen:
• Afgeronde opleiding op minimaal MBO-niveau;
• Ervaring in de financiële sector heeft de voorkeur;
• Kennis van Microsoft Office en voornamelijk Exel;
• Goede kennis van de Nederlandse taal, zowel mondeling als schriftelijk.
Wat zijn je werkzaamheden:
• Zelfstandig verwerken en controleren van administraties;
• Samenstellen van jaarrekeningen;
• Verwerken van fiscale aangiften;
• Persoonlijk en regelmatig contact met cliënten;
• Geven van financieel advies;
• Ondersteuning relatiebeheerders.
Ons aanbod:
Voor deze gevarieerde functie kun je rekenen op uitstekende arbeidsvoorwaarden.
Ons kantoor kenmerkt zich door een informele werksfeer en prettige werkomstandigheden.
Interesse?
Voldoe je aan het profiel en lijkt het je leuk om ons team te komen versterken?
Stuur dan jouw CV met motivatiebrief naar de heer C. Ekas: carlo@vdwinkelenpartners.nl.
Voor meer informatie kun je contact opnemen met de heer C. Ekas per mail of op 040-2858900.
Emopad 70 - 5663 PB Geldrop • Postbus 58 - 5660 AB Geldrop Telefoon (040) 285 89 00 • Internet: www.vdwinkelenpartners.nl

Ons bedrijf en filosofie: Vd Winkel & Partners te Geldrop is gespecialiseerd in advies op maat, administratieve dienstverlening, belastingadvies, loonadministratie en begeleiden bij financieringsaanvragen voor voornamelijk het midden – en kleinbedrijf. Persoonlijk en regelmatig cliëntencontact staat bij ons hoog in het vaandel, zodat wij goed op de hoogte blijven van de wensen van de cliënt. De kwaliteit van onze dienstverlening proberen wij steeds zoveel mogelijk te optimaliseren.
Functieomschrijving:
We zijn op zoek naar een zeer ervaren kracht die op zoek is naar mooie opdrachten uit de samenstelpraktijk van jaarrekeningen en daar ook volledig verantwoordelijk voor is.
De opdrachten zijn zeer gevarieerd. Ook voor consolidaties van BV structuren draai jij je hand niet om, wellicht heb je ook nog ervaring met het fiscaal afronden van de jaarrekeningen dan ben je helemaal op je plek bij ons.
Functie eisen:
• Je bent ambitieus;
• Je hebt al ruime ervaring als relatiebeheerder bij een administratie, of accountantskantoor en beheert en adviseert daar ook al serieus grotere cliënten;
• Je bent communicatief vaardig en weet met je rugzak aan ervaring hoe je je cliënt het vertrouwen geeft zodat hij met alle adviesvragen bij jou komt.
Wat zijn je werkzaamheden:
• Samenstellen van jaarrekeningen;
• Voorbereiden van fiscale aangiften;
• Persoonlijk en regelmatig contact met cliënten;
• Geven van financieel advies.
Ons aanbod:
Voor deze gevarieerde functie kun je rekenen op uitstekende arbeidsvoorwaarden.
Ons kantoor kenmerkt zich door een informele werksfeer en prettige werkomstandigheden.
Interesse?
Voldoe je aan het profiel en lijkt het je leuk om ons team te komen versterken?
Stuur dan jouw CV met motivatiebrief naar de heer C. Ekas: carlo@vdwinkelenpartners.nl
Voor meer informatie kun je contact opnemen met de heer C. Ekas per mail of op 040-2858900.














Asten, Weer of Veghel
• Ervaring met een autolaadkraan is een Pre
• Opleiding mogelijk
• Overnachtingen bespreekbaar


WIJ VRAGEN:
• Standplaats: Veghel
• Overnachtingen nvt.











WIJ VRAGEN:
• Standplaats: Venlo
• Overnachtingen nvt.
• Pre’s zijn vaste ritten, vaste werktijden



WAALRE - Theo Cox inwoner van Waalre, houdt een pleidooi voor de vogels in onze gemeente.
Er moet mij iets van het hart. Ik ben negentig jaar en al tachtig jaar heb ik vogels, zoals eksters, merels, kauwen, een Vlaamse gaai, een kraai en een Europese tortel. Ook had ik mussen, vinken, sijsjes et cetera. Heel mijn jeugd stond in het teken van vogels. En dat was in mijn tijd heel normaal. Veel jongeren hielden in die tijd vogels. Later had ik tropische vogels, en daar heb ik altijd veel mee gekweekt en plezier aan beleefd, tot op de dag van vandaag. Wij hadden in vroeger tijd al een vogelvereniging en organiseerden ieder jaar met groot plezier een tentoonstelling.
De verhalen die ik hoor over mensen die ons de vogels willen afnemen stemmen mij verdrietig. Zij beweren dat deze dieren niet in een kooi horen. Al sinds mensenheugenis hebben mensen vogels en andere dieren verzorgd en gegeten. We weten allemaal dat dat altijd al zo geweest is, en dat veel vogelsoorten in goede harmonie samenleven met de mens.
Gelukkig
Een man werkt bijvoorbeeld als timmerman op de bouw en is gelukkig in zijn huwelijk. Als hij ’s avonds thuiskomt gaat hij eerst naar zijn volière, want dat is zijn hobby. Hij heeft een paar verschil-

lende vogelsoorten die hij goed verzorgd en waarmee hij kweekt.
Ook hij houdt van tentoonstellingen en een vriendenkring.
Maar dan komt er een verandering in zijn leven. Er komt een
Partij voor de Dieren en die heeft als motto: vogels horen niet in een kooi. Die club wil dat alle vogels vrij in de natuur moeten kunnen rondvliegen, in een wereld die een grote bedreiging vormt voor onze dieren en planten. Er komen
vogelwetcontroleurs die bepaalde eisen stellen. De hardwerkende timmerman wordt er onrustig van en vreest dat zijn hobby wordt afgenomen. De Partij voor de Dieren heeft er ziet niet dat deze man met zijn hobby iets heel nuttigs doet. Door met de vogels te kweken houdt hij een voorraad -een buffer van bedreigde soorten- in stand. Dit is ook een manier om biodiversiteit in stand te houden. Op het moment dat het biotoop
in de vrije natuur weer hersteld en geschikt is, kunnen we proberen deze vogelsoorten weer uit te zetten in de natuur. Wetenschappers zijn op dit moment bezig om de mammoet terug te fokken. Dit wordt alom geprezen. Ik vind dit meten met twee maten.
Soorten verdwijnen
We weten dat bepaalde soorten vogels in de vrije natuur verdwijnen, zoals de wielewaal en de
grote lijster. Waar ik woon komen geen ringmussen meer voor en de zomertortel is ook verdwenen. Andere soorten zijn duidelijk in aantal afgenomen en dit beeld zet zich alsmaar voort. Dat de Partij voor de Dieren dit niet ziet is heel erg. Zij zou er juist voor moeten zorgen dat er zo veel mogelijk vogels en andere dieren die in aantal afnemen, gekweekt worden. Maar ook vogels die er nu nog voldoende zijn, moeten worden behouden. Zodra het territorium er geschikt voor is, kunnen de dieren weer worden uitgezet. En de timmerman is blij omdat hij zijn vogels mag blijven houden.
Generaties lang
Dus Partij van de Dieren, wees zuinig op de kwekers en op de vogels die we nog in onze volières hebben. Want het zijn dieren die al generaties lang in volières gekweekt worden. Voor mij, een man van 90, was de natuur uit mijn jeugd een normaal beeld. Voor de kinderen van nu, is de situatie zoals die nu is het normale beeld van de natuur. Maar vergeleken met de natuur in mijn jeugd is deze zoals die nu is, voor 90% afgestorven.
Liefhebbers die vogels als hobby hebben, worden gelukkig van het verzorgen van hun dieren. Een gelukkig mens functioneert beter. Uit dat oogpunt is het houden van vogels óók nuttig.
WAALRE - Hierbij een overzicht van de verschillende activiteiten tijdens carnaval.
AWC De Keien
Vrijdag 13 februari
08:30 uur Jeugdprinses Jill en Prins Capreolus bezoeken met hun gevolg diverse scholen in Aalst-Waalre en Veldhoven.
15.11 uur Carnavaleske Vrij-mibo in De Oude Toren
19:11 uur De 33e Verbroedering van Keiengat met Bremspoersengat bij de Volmolen. Prins Capreolus van Keiengat en Roel d’un Urste van Bremspoersengat reiken elkaar de hand over de Dommel en slaan het eerste vaatje Dommelsch Carnavalsbier aan
Zaterdag 14 februari
10.00 uur Sleuteloverhandiging door burgemeester Oosterveer aan Prins Capreolus & Adjudant Equus en aan Jeugdprinses Jill en Adjudantes Noor en Giulia. Samen met de Baltrappers en de Boerenbruiloft. Met muzikale ondersteuning van de Keiendweilers en Keienkrakers
14:00 uur Grote optocht van Aalst naar Waalre.
16.00 uur Einde optocht en Prijsuitreiking optocht in Het KeienKlooster.
19:11 uur Gezellige carnavalsmuziek in het KeienKlooster met Pianoshow: Keys and Beats.
Zondag 15 februari
11.11 uur Carnavalsmis in de Willibrorduskerk te Waalre.
13.30 uur Familiedag in Het KeienKlooster georganiseerd door Keiskøn met als thema: DiscoDance
20.11 uur Thema-avond Film & TV in KeienKlooster.
Maandag 16 februari
10:30 uur Bezoek aan de Boerenbruiloft in het Huis van Waalre. Leon & Esther worden in de onecht verbonden.
14.00 uur Groot Kinderbal In Het KeienKlooster. Met 2 geweldige gastoptredens. Inclusief snoep en schmink.
20.00 uur Kapellenavond in Het KeienKlooster . Voor velen het muzikale hoogtepunt van de Carnaval. Met optredens van vele gerenommeerde dweilorkesten.
Dinsdag 17 februari
11.11 uur Anti-Kater brunch in de Volmolen met aansluitend verbroederingsbal; 3 verenigingen Waalre komen samen in de Volmolen
14.11 uur Kindercarnaval in Het KeienKlooster. Dinsdagmiddag sluiten we het kindercarnaval knallend af met Het Masked Ball.
16.30 uur Jeugdprinses Jill en Adjudantes Noor en Giulia sluiten Carnaval af en overhandigen de sleutel van Waalre terug aan wethouder Suzan van de Goor. 20.11 uur Vastenavondbal in Het KeienKlooster.
22.11 uur Prins Capreolus & Adjudant Equus overhandigen de sleutel van Waalre weer aan Burgemeester Marcel Oosterveer met

Zaterdag 14 februari trekt de grote optocht van Aalst naar Waalre. Aanvang is 14.00 uur.
aansluitend feestavond.
Woensdag 18 februari
18.30 uur Aswoensdagviering in de Willibrorduskerk (Waalre)
19.30 uur Aswoensdagviering in O.L.V. Presentatie Kerk (Aalst)
Meer informatie via de website: https://www.awckeien.nl/
Het KeienKlooster ligt aan de Jan van Genugtenstraat 1 in Waalre
Zaterdag 14 februari
Op zaterdag 14 februari openen we het carnavalsbal bij De Pracht.
Na afloop van de carnavalsoptocht barst het feest los en wordt het bal officieel geopend door dj’s Dirk & Frank, die zorgen voor een gezellige carnavalsstemming.
Ook aan de jongste feestvierders is gedacht: voor de kinderen staat er heerlijke ranja klaar en is er volop ruimte om mee te hossen en plezier te maken.
20.00 Partynight – Carnaval voor de jeugd (11-15 jaar) een eigen plek om carnaval te vieren, helemaal zonder ouders. Met een toffe DJ, lekkere popcorn, drankjes en feestelijke mocktails wordt het één groot carnavalsfeest.
De Partynight is van 20.00 tot 01.00 uur. De entree bedraagt €5, inclusief twee consumptiebonnen.
Zondag 15 februari Familiemiddag
Vanaf 14.00 uur is het weer tijd voor de traditionele familiemiddag bij De Pracht. Al jarenlang is deze zondagmiddag een geliefde traditie tijdens carnaval, waar jong en oud samenkomen voor een gezellige middag. De zaal staat weer lekker vol en DJ’s Dirk & Frank zorgen voor opzwepende en vrolijke muziek. Voor de kinderen is er van alles te beleven: zo is er een speciale kinderkraam, een gezellige kinderhoek voor wie even een rustmomentje wil, en natuurlijk is ook de inmiddels zeer bekende Clown Makkie weer van de partij met zijn kleurrijke ballonnen. Ook aan live-entertainment geen gebrek. Sambaband Os Malandros heeft al toegezegd langs te komen voor een spetterend optreden. Daarnaast wordt ook een bezoek verwacht van CV De Baltrappers, wat de middag extra feestelijk maakt.
Dinsdag 17 februari: kindercarnaval middag
Vanaf 14.00 uur tijd voor een gezellige kindercarnavalmiddag bij
De Pracht. Een middag vol muziek, plezier en verrassingen voor de jongste carnavalsvierders. DJ Bjorn zorgt – net als vorig jaar – voor supertoffe muziek waar niemand bij stil kan blijven staan. Ook clown Makkie is natuurlijk weer van de partij en verrast de kinderen met zijn mooiste en leukste balloncreaties.
REGIO – Voor mensen met een stoma en hun omgeving is contact met andere stomadragers belangrijk. Zij weten van elkaar hoe het is om met een stoma te leven. Daarom houdt de Stomavereniging op dinsdag 17 februari een lotgenotencontact voor stomadragers, partners en belangstellenden.
Deze vindt plaats bij Centrum De Eik: Klein Tongelreplein 8 in Eindhoven. Het begint om 14:00 uur en we ronden af om 16:00 uur. Navigatie en gratis parkeergarage: Crabethstraat 18, 5613 JZ Eindhoven.
De Stomavereniging houdt elke derde dinsdag van de maand een bijeenkomst in Eindhoven, zodat leden en andere belangstellenden elkaar kunnen ontmoeten.
Daarnaast krijgen bezoekers veel informatie over leven met een stoma. Aanmelden is niet nodig.
Heeft u vragen, neem contact op met Bart ter Stege: b.terstege@stomavereniging.nl
Meer weten over het werk van de Nederlandse Stomavereniging? Kijk eens op: www.stomavereniging.nl

De Stomavereniging houdt op dinsdag 17 februari weer een lotgenotenbijeenkomst in Centrum de Eik.
BRABANT – Carnaval en Omroep
Brabant horen onlosmakelijk bij elkaar. In alle hoeken van de provincie wordt carnaval gevierd: ieder dorp en elke stad met zijn eigen gebruiken, rituelen en tradities. Al die vormen van carnaval komen samen op één plek: Roeptoetgat.
Van de eerste klanken van 3 Uurkes Vurraf tot het moment waarop de laatste feestvierder de tv of radio uitzet, brengt Roeptoetgat, Brabant samen in de carnavalsgekte.
Roeptoetgat
Tijdens carnaval draagt Omroep Brabant de naam Roeptoetgat. Vier dagen lang is er 24 uur per dag carnaval op alle kanalen: online, op radio én tv en op Brabant+. De aftrap is vrijdagmiddag 13 februari met 3 Uurkes Vurraf en het feest gaat door tot en met dinsdagavond 17 februari, wanneer in het Fijnfisjenie Café de laatste lichten doven. Verslaggevers én de Roeptoetmobiel trekken door heel Brabant langs feesten, optochten en de meest enthousiaste carnavalsvierders.
3 Uurkes Vurraf
Voor de 37e keer vormt 3 Uurkes Vurraf de officiële aftrap van carnaval 2026. Live vanaf het Stadhuisplein in Eindhoven klinken drie uur lang de grootste carnavalskrakers van dit seizoen, afge-
In de dagen voor carnaval hangt er iets in de lucht op onze locaties. Zachte voorpret. Een liedje dat iemand neuriet. Een glimlach bij het zien van kleurrijke versieringen. Carnaval komt hier binnen met herinneringen.
Marij Rottier (75) hoeft niet lang na te denken. “Carnaval roept bij mij een heel goed gevoel op,” zegt ze. Als kind stond ze langs de kant bij de optochten in Riethoven. “Mijn eerste keer stappen was met carnaval. In hotel Royaal in Valkenswaard.” Ze lacht: “Daar leerde ik mijn man kennen.” Ook nu doet ze graag mee aan de activiteiten op Kempenhof. “De minizitting, de optredens in het restaurant — dat vind ik gezellig.”
Bij Francine Boelens (87) roept carnaval meteen plezier op. “Blijdschap,” zegt ze beslist. “En de smaak van snapjes drinken,” voegt ze er lachend aan toe. Haar gedachten gaan terug naar vroeger. “Het plezier van ernaartoe leven, altijd met dezelfde groep. Eén jaar stemden we onze verkleedkleren op elkaar af. We waren samen een stok kaarten: harten, ruiten, schoppen en klaver. Daar kon je een prijs mee winnen.”
Als kind ging ze met een foeperpot langs de deuren — een pot met een varkensblaas en een rietje, dat samen geluid maakte — voor een snoepje of stuk fruit. Later kwam het uitgaan. “Ik ben zelfs een keer tamboer-maitre geweest
bij de Harmonie in Westerhoven.
Mijn man kon niet en ik zei dat ik het wel wilde doen.” Met haar leefgroep op Valkenhof viert ze het nog steeds: een carnavalslunch, verkleed in pyjama. En de activiteiten op Kempenhof. “Dat blijft leuk!”
Ook Miet Damen (89) krijgt een glimlach. “Carnaval maakt me nostalgisch,” zegt ze. “Het is met de paplepel ingegoten.” Ze herinnert zich hoe het begon met haar ouders, later met eigen kinderen. “We gingen vaak naar de Dennenberg, de rolschaatsbaan.
Altijd met vrienden en familie.” Het begon al met de voorpret. “De voorbereidingen, het samen zijn, de drankjes. Ik ben een echt gezelschapsmens.” Ook nu leeft dat gevoel volop. Vorig jaar was ze Prinses Carnaval op de Zoete Inval. “Ik doe met alle activiteiten mee die georganiseerd worden. Dat vind ik heerlijk.”
En dat maakt carnaval bij Valkenhof zo bijzonder. Het herinnert aan vroeger én leeft vandaag.
Fijne carnaval. Leef de dag. Alaaf!


wisseld met publieksfavorieten.
Op het podium staan onder anderen Lamme Frans, Jan Biggel, De Alpenzusjes, Gebroeders Ko, Jeroen van Zelst, René Schuurmans en Veul Gère. Ook de winnaar van Kies je Kraker is erbij. De presentatie is in handen van Jordy Graat. De live-uitzending start om 15.00 uur.
Wie alvast wil opwarmen, kan vanaf 13.00 uur terecht bij 2 Uurkes Vurgloeie. Maarten Kortlever en Koen Wijn zorgen voor de juiste sfeer met de grootste hits van dit jaar, bekende klassiekers én een kijkje achter de schermen bij 3 Uurkes Vurraf. Te zien en horen op radio, tv en online.
In Roeptoetgat is er ook dit jaar volop aandacht voor de mooiste carnavalsoptochten in Brabant. Alle optochten zijn live te zien op tv en ook te volgen en terug te kijken via Brabant+ en omroepbrabant.nl/carnaval. Ook op de radio is het onafgebroken carnaval met Dweilradio. Radioverslaggevers trekken met de Roeptoetmobiel, inclusief grote Roeptoeter op het dak, door de provincie om de sfeer van Brabant vast te leggen. Alle informatie over het carnavalsaanbod van Omroep Brabant vind je op www.omroepbrabant. nl/carnaval.
Pieter Verelst met nieuwe comedyshow ‘Altijd Aan’

VALKENSWAARD – Pieter Verelst staat met zijn nieuwe show op zaterdag 21 februari Theater De Hofnar. Hij geeft een eerlijke inkijk in wat er werkelijk allemaal gaande is in zijn absurde hoofd.
‘Atijd Aan’ is een herkenbare voorstelling over graag willen leven, alles willen meemaken, veel zijn voor anderen, maar toch net iets te weinig voor jezelf. Hoe word ik normaal? Wil ik wel normaal zijn? En wat is er mis met een beetje chaos en een unieke kijk op de wereld?
De Vlaamse acteur en cabaretier
Pieter Verelst zette zijn eerste comedystappen in Nederland in zijn studietijd. In 2014 debuteerde hij met zijn comedyshow ‘Mijn Broer en Ik’ en won hij meteen het Groninger Studenten Cabaret Festi-
val. Twee jaar later won hij ook Cameretten.
Met zijn tweede comedyshow ‘Amai’ en zijn volgende, ‘Ten Aarzel’, heeft hij zich op de kaart gezet als comedian. Hij wordt gezien als een van de spannendste comedians van zijn generatie.
Info & kaarten
De kaartverkoopbalie is geopend op ma t/m vr van 13.00 tot 17.00 uur (040-2074010) of mail naar kaartverkoop@hofnar.nl Kijk voor meer informatie op www.hofnar.nl














op Auping artikelen, zoals bedden, boxsprings, matrassen en beddengoed 21% korting 25% korting 20% korting tot tot op Vandyck luxe bedtextiel, heel veel keuze uit dessins en maten! 40% korting
* Profiteer van 15% korting op geselecteerde TEMPUR® producten. De promotie is geldig van 17 december 2025 t/m 15 februari 2026. Vraag uw verkoopadviseur naar de voorwaarden. Laatste week!
op een Tempur form boxspring en matras(sen) op SLP bedden, matrassen, dekbedden, kussens en nog veel meer (m.u.v. spiraalbodems)


www.beddenspecialist-houben.nl





je knuffel mee naar het
REGIO - Een ziekenhuisbezoek kan spannend zijn voor kinderen. Daarom organiseert Máxima MC op zaterdag 14 maart het Teddyberenziekenhuis: een speelse en ontspannen manier voor kinderen om kennis te maken met het ziekenhuis.
Kinderen mogen hun zieke knuffel meebrengen naar het Teddyberenziekenhuis, waar echte berendokters klaarstaan om hen te helpen. Samen onderzoeken ze de knuffel in de onderzoekskamer, maken een röntgenfoto en leggen verbandjes of gips aan.
Meer informatie
Het Teddyberenziekenhuis vindt plaats op de kinderdagbehandeling van Máxima MC, De Run 4600
in Veldhoven. Het Teddyberenziekenhuis is geopend tussen 10.00 en 13.00 uur. Om iedereen rustig en goed te kunnen ontvangen, wordt gewerkt met drie vaste tijdsloten. Aanmelden is verplicht. Tijdens het aanmelden kies je eenvoudig een tijdslot dat het beste uitkomt. Zonder aanmelding kunnen we helaas geen toegang geven. Aanmelden via: www.mmc.nl/teddyberenziekenhuis

VOETBAL - DVS ontving zondag koploper Maarheeze en wist vooraf dat het een lastige middag zou worden. Die verwachting kwam al snel uit, want Maarheeze begon fel en zette DVS direct onder druk.
Door Jacqueline Senders
In de openingsfase had DVS moeite met de druk. Passes en acties waren te doorzichtig en werden goed gelezen door de bezoekers. De eerste kans was dan ook voor Maarheeze, maar Ralf van Beek schoot naast.
Na twaalf minuten was het alsnog raak. Cas Baudoin won het duel met Fin van den Hoogen en haalde uit richting doel. Via Rens Kuijpers verdween de bal achter doelman Giovanni Prinsen: 0-1. DVS moest alert blijven op de snelle aanvallen van Maarheeze. Het was dan ook geen verrassing dat nog geen kwartier later de 0-2 viel. Van Beek passeerde Finn van Eck en legde de bal breed op de vrijstaande Baudoin, die eenvoudig binnentikte.
Direct daarna volgde een spaarzame tegenaanval van DVS, maar de omhaal van Dries Kreijns leverde geen gevaar op. Aan de andere kant kwam DVS goed weg toen Baudoin opnieuw gevaarlijk werd, zijn voorzet Van Beek bereikte en diens inzet op de paal belandde. Even later wist Prinsen met een knappe redding een
VOETBAL - Waalre heeft tegen koploper Marvilde een volledig kansloze wedstrijd gespeeld. In alle facetten van het spel waren de gasten uit Meerveldhoven oppermachtig daarbij Waalre dwingend de meest kinderachtige fouten te maken. Doordat de gasten in de slotfase de meeste riante mogelijkheden lieten liggen bleef de schade voor de thuisploeg beperkt tot de duidelijke cijfers van 0-6.
Door Toon van Dijsseldonk
Vanaf het begin van de wedstrijd, heeft Waalre geen enkel moment de indruk gewekt dat er tegen de koploper eer te behalen viel. Al na 9 minuten kwam de ploeg op achterstand toen té eenvoudig een vrije trap werd weggegeven op de rand van het strafschopgebied. Namens Marvilde gaf Twan Demin vervolgens doelman Koen de Waal het nakijken, 0-1.
Vervolgens was het met doelgevaar lange tijd gedaan. Waalre kwam niet eens tot een enkel schot op het Marvilde-doel terwijl de gasten lange tijd slordig speelde. Na een half uur viel dan toch de 0-2 toen opnieuw Twan Demin volkomen vrijstaand zijn tweede van de middag, kon binnen koppen.
Vijf minuten leverde ook topscorer Sander Megens zijn bijdrage toen hij aan het einde van een vloeiende aanval stond en de 0-3

Een van de spaarzame momenten dat Waalre in de aanval ging. (Foto: Toon van Dijsseldonk)
tegen de touwen kon schieten.
Tweede helft
Na rust kwam er een fase in de wedstrijd waarin het leek alsof Waalre de doelpunten zomaar weg gaf. In de 46e minuut liet iedereen van de Waalrese ploeg de bal zomaar passeren zodat Ruben Dillen de bal voor het intikken had: 0-4. In de 55e minuut een doelpunt als gevolg van de opbouw vanuit de achterhoede bij Waalre die totaal niet beheerst wordt. Nu speelde doelman Koen de Waal de bal plotseling breed voorlangs het door hem verlate doel. Doordat Daan Siebers vervolgens deze niet onder controle kreeg was het voor Rik Janssens een koud kunstje om de 0-5 bin-

te passeren (Foto: Jan Senders)
derde treffer te voorkomen. Met een 0-2 achterstand zochten beide ploegen de kleedkamers op.
Tweede helft
Na rust probeerde DVS meer grip te krijgen op de wedstrijd. Kreijns kreeg al snel een kans, maar zijn schot ging net over. Het offensievere spel gaf echter ook meer ruimte weg. Een voorzet van Maarheeze bereikte de vrijstaande Karsten Hulsbosch, die de bal doorgaf aan Van Beek. De spits rondde koelbloedig af: 0-3. Maarheeze liet het initiatief daarna meer aan DVS dat hierdoor beter in het spel kwam. Grote kansen bleven lange tijd uit, mede doordat de verdediging van
Maarheeze sterk was. DVS bracht de spanning terug nadat Fin van den Hoogen de 1-3 binnenschoot. DVS ging op jacht naar de aansluitingstreffer waardoor er ruimte ontstond voor Maarheeze. In de 84e minuut leek de beslissing te vallen met de 1-4, maar deze werd wegens buitenspel afgekeurd. Ondanks een duidelijk betere tweede helft en meerdere kansen in de slotfase slaagde DVS er niet in om nog dichterbij te komen. Maarheeze bleef overeind en stapte uiteindelijk als terechte winnaar van het veld. De eerstvolgende wedstrijd van DVS is op zondag 1 maart, uit tegen FC Eindhoven AV. De wedstrijd begint om 14.30 uur.
Waalrese schutters schitteren op NK Handboogschieten
HANDBOOGSCHIETEN - Voor HSV De Vriendschap uit Waalre was het afgelopen weekend een bijzonder succesvol NK Indoor Handboogschieten. In Den Bosch kwamen drie Waalrese schutters in actie, en alle drie keerden ze met eremetaal huiswaarts.
De Waalrese deelneemsters Fenna Stallen (15) en Aria Inglis (11) schoten bij de jeugdkampioenschappen beide een sterke wedstrijd. Fenna plaatste zich overtuigend als nummer één voor de finales. Aria mocht met haar vierde plek eveneens door naar de finales waar zij brons behaalde. Fenna wist haar nationale titel succesvol te verdedigen en pakte met 145-140 opnieuw het goud in de compoundklasse.
De senioren kwamen op zaterdag in actie. Ondanks materiaalpech in de eerste series schoot Willem Bakker zich naar de finales. Fenna kwalificeerde zich als tweede. In de eliminaties schoten zowel Fenna als Willem zich overtuigend richting de gouden finales. Met één punt verschil kroonde Fenna Stallen zij zich tot Nederlands kampioen compound dames 2026. Willem maakte er tegen Sjef van den Berg een spannende wedstrijd van, maar moest in de laatste set nipt buigen. Hij won zilver.
nen te tikken. Langzaam maar zeker leek een echte monsterscore in de maak, zeker nadat in de 62e minuut Twan Demin zijn derde treffer en de zesde van Marvilde binnen schoot, 0-6. In de slotfase kreeg Marvilde vervolgens de ene na de andere riante kans maar voor de spelers uit Meerhoven was het kruit blijkbaar verschoten en bleef Waalre verdere schade bespaard.
Programma
Waalre kan met de carnavalsdagen in aantocht, het hoofd leeg gaan maken zodat ze er op zondag 1 maart weer staan. Dan speelt de ploeg uit tegen Knegselse Boys. De wedstrijd begint om 14.30 uur.



(Foto: Paul Dodemont)

Onze lezers stuurden weer veel mooie foto’s in wat de keuze voor de redactie er niet makkelijker op maakt. Maar alle foto’s zijn meer dan welkom. Heeft u een (liggende/horizontale/landscape!!!) foto die u wilt delen? Stuur deze foto in het originele formaat (minimaal 1 Mb) met een korte begeleidende tekst, naar: deschakel@dasmediacentrum.nl


Ochtendwandeling (Foto: Yvonne van den Bergh)




Schuilplaats (Foto: Leo de Greef)




Ontbijt! (Foto: Peter van Kruijssen)

Zwaluwenwand (Foto: Karin van Berkel)

Sneeuwwandeling (Foto: Ester van Beers)















WAALRE - Waalrenaar Arno ter Burg organiseert op woensdag 25 februari een bijzonder benefiet-diner bij restaurant Eden, Oude Torestraat in Waalre, met een veiling en loterij.
Voor de veiling heeft hij veel geweldige items ontvangen: van zweefvliegen, tot schilderworkshops, kunstwerken, hotelovernachtingen tot beautybehandelingen en exclusieve diners tot workshops voor gezinnen in musea, theaterkaarten, leuke items van Jochem Myjer tot een gesigneerd shirt van Guus Til (PSV) en de Nederlandse schrijfster Marion Pauw heeft een geweldig item beschikbaar gesteld en veel meer.
Praktische informatie
De kosten voor het benefietdiner bedragen per persoon 175 euro. Chefkok en eigenaar van Eden, Herman Cooijmans zorgt voor een geweldig 4-gangen diner inclusief mousserende aperitief en 3 consumpties.
Tijdens deze avond vindt de loterij plaats en na afloop is er de veiling.
Aanmelden voor dit benefiet-diner kan via mail naar: a_ter_burg@hotmail.com.
Via dit mailadres kunt u ook bieden op de veilingitems.
Meedoen aan de loterij kan door middel van het kopen van lootjes: 1 lot kost 5 euro, 5 loeten kosten
WAALRE - Regelmatig ontvangt de redactie van onze lezers en inzenders van berichten, foto’s die niet geschikt zijn om te plaatsen. En dat is jammer.
Helaas zijn wij gebonden aan vaste redactievormen in de krant waar we alleen liggende of horizontale foto’s op kunnen plaatsen.
Wat kan niet
- geen staande/verticale foto’s plaatsen. dus gewoon even de telefoon draaien naar een horizontale stand; - geen verkleinde foto’s, foto’s moeten minimaal 1 Mb groot zijn; - geen foto’s die in een mail of Word-document zijn geplakt. De foto’s worden hierdoor automatisch verkleind naar een formaat dat niet meer te gebruiken is;
- geen foto’s met tekst of logo’s erin, geen flyers;
Wat kan wel - horizontale of zogenoemde liggende foto’s;
- als losse jpeg-bijlage bij een mail gevoegd; - in een hoge resolutie van minimaal 1Mb.
Neem bij twijfel, gewoon even contact met ons op, dan kijken wij wat mogelijk is.

20 euro en voor 13 loten betaalt u 50 euro.
Betalingen voor de loten kunt u doneren via de sponsorpagina van KiKa: https://supporta. com/19cn/mjlx9qljep?utm_ campaign=fundraiser_page
De prijzen voor de loterij en de items voor de veiling zijn te vinden via: arnoterburgrentvoorkika.wordpress.com
De volledige opbrengst van de veiling en de loterij gaat naar KiKa.
Over Arno ter Burg
Waalrenaar Arno ter Burg is pi-
anist, componist en arrangeur (o.a. bij het Nederlands Blazers Ensemble) en dirigent bij diverse koren en werkzaam bij het CKE, Cultuur & Kunst Eindhoven. “Al vanaf 2017 zet ik mij (sportief) in voor de stichting KiKa (Kinder Kankervrij). Inmiddels heb ik al bijna 70.000 euro opgehaald voor deze mooie stichting door middel van allerlei acties. Denk aan benefietconcerten (met Herman van Veen), ludieke acties, sponsorlopen, tot loterijen en veilingen tijdens een exclusief diner. In augustus 2026 ga ik de marathon van Sydney rennen (dat wordt mijn 7e major marathon voor KiKa). Hier wil ik weer een enorm bedrag voor ophalen.”

Ad Dams en Corrie Overweg exposeren vanaf zaterdag 21 februari in de Pracht
WAALRE - Corrie Overweg en Ad Dams exposeren vanaf vrijdag 21 februari in De Pracht. Met overeenkomsten in onderwerp als het alledaagse en de mens in zijn eenvoud en arbeid. Maar eveneens met grote verschillen in hun realistische uitingen en aanpak.
Ad Dams werkt veelal vanuit een krabbel en met grote tussenpozen aan wat hij opdiept uit zijn geheugen en verwerkt in zijn spaarzame vrije tijd. Corrie Overweg daarentegen gaat een stap verder in haar realistisch werk met een verdieping in emotie, gevoel en beleving. Het werk is voor haar pas af als diegene die het ziet, het zien kan voelen en beleven.
Deze interessante expositie van beide kunstenaars uit Waalre wordt officieel geopend op vrijdag
Heilige Willibrorduskerk
Aanspreekbare pastor: Diaken drs. A.A. (Andreas) Inderwisch
Pastorie Waalre: Markt 23, Waalre. Tel. 040-2212732 info@willibrord-waalre.nl
Eucharistievieringen: zondag om 11.00 uur; dinsdag en donderdag om 12.00 uur.
OLV Presentatiekerk
Aanspreekbare pastor: Kapelaan drs. E.H.R.C.M. (Erik) Buster
Pastorie Aalst: Eindhovenseweg 63, Aalst-Waalre. Tel.: 040- 2212285. info@willibrord-aalst.nl
Eucharistievieringen: woensdag en vrijdag: 19:00u.; zaterdag 17.00 uur; zondag 09.30 uur; Eucharistische aanbidding: woensdag aansluitend aan eucharistieviering tot 20:00 uur
Protestantse gemeente Agnus Dei-kerk
Koningin Julianalaan 12 Waalre info@adkerk.nl
Open kerk/Ontmoeting en gesprek: elke vrijdag van 10.00 tot 12.00 uur
Kerkdienst:
Elke zondag om 10.00 uur is er een kerkdienst die ook (eventueel later) online te volgen is via: www.adkerk.nl/agenda
Voorganger zondag 15 februari Ds. H. Veltkamp uit Zaltbommel www.adkerk.nl/agenda
Trinity Church Eindhoven
Church of England, De Pracht 1 in Aalst.
Engelstalige vieringen: elke zondag 10.30 uur. Kindernevendiensten voor verschillende leeftijdsgroepen. Ook in het Nederlands mogelijk.
Chaplain: Harrison Ephraim, tel. 06-87285086
Congregational Worship Leader: Kris Pol, tel. 06-13715677
Wegwijzer
Dienst huisartsen
De huisartsen uit Waalre nemen deel aan de dienstenstructuur van SHOKO in het Maxima MC in Veldhoven.
Bij spoedeisende medische klachten op maandag tot en met vrijdag tussen 17.00 uur en 08.00 uur en het gehele weekend telefonisch bereikbaar onder: Telefoonnummer: 040 – 2660505.
Dienst tandartsen
De dienstdoende tandarts is, uitsluitend voor spoedgevallen, te bereiken via het centrale telefoonnummer: 0900-2041177.
Thuiszorg
Verpleeg Collectief biedt alle vormen van zorg/verpleging: dagdelen vanaf 4 uur aaneengesloten; nachten; 24-uurszorg.
Burgemeester Mollaan 28, 5582 CK in Waalre. Tel.nr. (dag en nacht): 040-2215271. www.verpleegcollectief.nl
Dynamo Jeugdwerk Waalre
27 februari van 16.00-18.00 uur.
Meer informatie
De werken die in de ontvangstruimte hangen, zijn te bezichtigen gedurende de openingstijden van De Pracht. Er hangen ook werken van beide kunstenaars in de overige zalen op de begane grond, die alleen toegankelijk zijn als die zaal niet in gebruik is.
De entree is gratis.
Deze expositie is te zien tot woensdag 20 mei.
Dynamo Jeugdwerk biedt in Het Klooster en in De Pracht diverse activiteiten aan voor de jeugd. Meer informatie via de Facebookpagina: www.facebook.com/DynamoJeugdwerkWaalre
Goed voor Mekaar Waalre
Dé plek voor vrijwilligerswerk en informele hulp, zoals begeleid vervoer, hulp bij boodschappen en kleine klusjes, mantelzorg en bezoek- en belmaatjes. Tel.nr. 06-25762422 (maandag t/m vrijdag van 09.30 tot 12.00 uur).
Meer informatie: www.goedvoormekaarwaalre.nl
Cordaad Welzijn
Een brede welzijnsorganisatie; werkzaam in de A2, Veldhoven en de Kempen. In Waalre bieden ze Thuisadministratie (op orde brengen van papieren), Buurtbemiddeling (hulp bij burenruzies) en VPTZ (vrijwillige palliatieve thuiszorg). Alles in samenwerking met de mensen zelf en vaak door vrijwilligers.
Meer informatie: tel.nr. 040-253 3443 www.cordaadwelzijn.nl
Bij overlijden
Van der Stappen Uitvaartverzorging
Felix Timmermanslaan 2, Eindhoven.
Te bereiken via tel.nr.: 040-2212550 www.vdstappen.nl
Uitvaartzorg Hans Raaijmakers, Emopad 56 in Geldrop, Te bereiken via tel.nr.: 040-7808000, www.hansraaijmakers.nl
Rian van Leest Uitvaartverzorging Rouwcentrum ‘t Dennehuys, Dennelaan 1 in Waalre. Te bereiken via tel.nr.: 040-2121071 www.rvlu.nl
Coöperatie DELA T 040 200 12 99 | dela.nl | 24/7 bereikbaar om te helpen in Waalre
Motor – Tennis – Kaarten – “Biertje”
Na een periode van afnemende gezondheid is rustig ingeslapen mijn maatje
echtgenoot van Mien Hoeks-van Poppel
* Valkenswaard, 21 juni 1947
† Valkenswaard, 28 januari 2026
Mien
Keesje 5
Familie Hoeks
Familie Van Poppel
Zeelberg 40
5555 XG Valkenswaard
Het afscheid van Piet heeft in besloten kring plaatsgevonden.




van Roozendaal Sarah van Hout-Trienekens RU



‘Een persoonlijk en bijzonder afscheid voor iedereen.’

Nicole Schuiring | uitvaartverzorger bij DELA
Met mijn betrokken collega’s in de regio Valkenswaard help ik u om samen de uitvaart geheel naar wens vorm te geven. Er is vaak nog veel meer mogelijk dan u denkt. Met aandacht en zorg ondersteunen wij u voor, tijdens en na de uitvaart. Iedereen kan bij ons terecht voor een persoonlijk en bijzonder afscheid. Ook als er geen uitvaartverzekering is.
Wilt u meer informatie of een persoonlijk gesprek? Kijk op dela.nl/valkenswaard of bel 040 200 10 83





Persoonlijke dienstverlening ongeacht óf en waar u verzekerd bent Waalre, Aalst, Eindhoven, Valkenswaard en omstreken


Na afloop opwarmen et een







i ter and lin met IVN Heeze-Leende pmet warme kop snert







































































c rijf u gra is in e ontdek a uur egraafplaats Schoorsveld
taa e s st l ij
Staat u wel eens stil bij het afscheid dat ooit zal komen?
T e s d interwan eli g o n t gr a aa S hoorsve d vaart d rstilde tuur it s iz n
Tijdens de winterwandeling op natuurbegraafplaats Schoorsveld ervaart u de rust, de ruimte en de verstilde schoonheid van de natuur in dit seizoen
ndel amen e e n v n I N
ek laats e rustpla ts k n la dschap n ge ijk aa blijvend
Wandel samen met een gids van IVN Heeze-Leende mee en ontdek hoe een laatste rustplaats kan opgaan in het landschap en tegelijk bijdraagt aan blijvende natuur.
Inschrijven via: schoorsveld.nl/IVN-wandeling
hrijven v a sch ors eld nl IVN a delin
Natuurbegraafplaats Schoorsveld, Heeze
Dinsdag 17 februari 10 30 uur

Somerenseweg 116
Scan de QR-code en meld u aan
5591 TN, Heeze | 040 303 23 00








Relaxfauteuil Twice 222

3 motoren met accu van €3471
Mill | Schoolstraat 26a
Riethoven | Dorpsstraat 15
Reusel | Schoolstraat 29


Waarom kiezen voor Dit Zit?

✔ Gratis levering


✔ 5 jaar garantie
✔ Vaste lage prijzen
✔ Maat xs tot XXL
✔ Nederlandse merken
✔ Klanten geven ons een 9,7

✔ 797 relaxstoelen direct op voorraad
040-2013103 | DITZIT.NL |
Dinsdag t/m zaterdag 10.00-17.00
Voor de deur parkeren